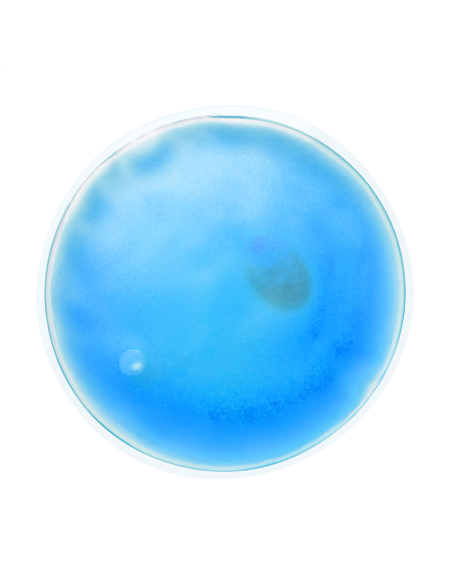
Polštářek tepelný

|
|
|
|
|
|
|
|
|
|
|
|
|
|
|
|
|
|
|
|
|
|
|
|
| aster |
rgb(213,214,231) |
|
purple |
|
|
| prune |
rgb(110,39,55) |
|
burgundy |
|
|
| ray |
rgb(250,227,157) |
|
yellow |
|
|
| thyme |
rgb(131,128,109) |
|
khaki |
|
|
| latte |
rgb(215,199,184) |
|
cream |
|
|
| fog |
rgb(199,215,228) |
|
sky |
|
|
| birch |
rgb(246,239,233) |
|
cream |
|
|
| steel |
rgb(64,68,80) |
|
grey |
|
|
| rich violet |
rgb(74,50,126) |
|
purple |
|
|
| strawberry red |
rgb(213,29,37) |
|
red |
|
|
| pale violet |
rgb(170,178,214) |
|
purple |
|
|
| dark violet |
rgb(94,72,183) |
|
purple |
|
|
| champagne |
rgb(229,181,169) |
|
pink |
|
|
| washed dark navy |
rgb(22,30,41) |
|
navy |
|
|
| washed dusky khaki |
rgb(43,41,28) |
|
army |
|
|
| washed brandy |
rgb(105,49,12) |
|
brown |
|
|
| white/oxford blue |
rgb(254,254,254) |
rgb(164,175,203) |
white |
blue |
multicolor |
| white/pink |
rgb(254,254,254) |
rgb(217,206,222) |
white |
pink |
multicolor |
| oxford blue |
rgb(143,163,196) |
|
blue |
|
|
| mid blue |
rgb(131,138,186) |
|
sky |
|
|
| port |
rgb(103,63,72) |
|
burgundy |
|
|
| bright sky |
rgb(158,181,222) |
|
sky |
|
|
| black denim |
rgb(61,61,61) |
|
black |
|
|
| ledově bílá |
rgb(212,213,217) |
|
white |
|
|
| midnight navy |
rgb(41,51,61) |
|
navy |
|
|
| stonewash denim |
rgb(184,198,209) |
|
sky |
|
|
| bone |
rgb(231,230,217) |
|
cream |
|
|
| graphit black |
rgb(61,60,56) |
|
dark |
|
|
| shitake |
rgb(153,145,142) |
|
grey |
|
|
| light asphalt |
rgb(185,184,180) |
|
grey |
|
|
| iris blue |
rgb(60,73,105) |
|
blue |
|
|
| bright turquoise |
rgb(1,126,158) |
|
turquise |
|
|
| marsala |
rgb(139,82,91) |
|
pink |
|
|
| arandano red |
rgb(187,47,58) |
|
red |
|
|
| curcuma |
rgb(216,148,63) |
|
yellow |
|
|
| cummin yellow |
rgb(215,128,63) |
|
orange |
|
|
| dusty light green |
rgb(89,97,82) |
|
green |
|
|
| cool grey |
rgb(144,144,144) |
|
grey |
|
|
| washed steeple grey |
rgb(113,103,104) |
|
grey |
|
|
| washed kombu green |
rgb(86,81,62) |
|
army |
|
|
| washed green clay |
rgb(142,139,120) |
|
army |
|
|
| washed cinnamon |
rgb(139,92,62) |
|
brown |
|
|
| washed russet |
rgb(143,91,70) |
|
brown |
|
|
| natural/bottle green |
rgb(250,236,193) |
rgb(29,51,38) |
cream |
bottle |
multicolor |
| hazelnut |
rgb(135,108,89) |
|
brown |
|
|
| rose quartz |
rgb(129,94,91) |
|
pink |
|
|
| moonstone |
rgb(156,151,145) |
|
cream |
|
|
| dark emerald |
rgb(22,44,32) |
|
bottle |
|
|
| oyster |
rgb(214,207,189) |
|
cream |
|
|
| nude pink |
rgb(197,164,149) |
|
pink |
|
|
| blue grey |
rgb(90,100,112) |
|
blue |
|
|
| patriot blue |
rgb(5,7,12) |
|
navy |
|
|
| delphinium blue |
rgb(73,124,128) |
|
turquise |
|
|
| light violet |
rgb(174,160,196) |
|
purple |
|
|
| radiant orchid |
rgb(162,92,155) |
|
pink |
|
|
| fluorescent fuchsia |
rgb(165,62,109) |
|
pink |
|
|
| light marsala |
rgb(155,95,94) |
|
pink |
|
|
| glacier grey |
rgb(175,175,175) |
|
grey |
|
|
| dark red |
rgb(161,44,53) |
|
red |
|
|
| black/fuchsia |
rgb(0,0,0) |
rgb(229,44,132) |
black |
pink |
multicolor |
| fuchsia/black |
rgb(229,44,132) |
rgb(0,0,0) |
pink |
black |
multicolor |
| kentucky blue |
rgb(174,186,208) |
|
sky |
|
|
| winter night |
rgb(10,26,52) |
|
navy |
|
|
| raw sugar |
rgb(129,27,22) |
|
red |
|
|
| pearl skin |
rgb(208,174,165) |
|
pink |
|
|
| detox green |
rgb(74,85,68) |
|
green |
|
|
| white/taupe |
rgb(254,254,254) |
rgb(90,59,57) |
white |
brown |
multicolor |
| white/anthracite |
rgb(254,254,254) |
rgb(44,45,40) |
white |
dark |
multicolor |
| pop |
rgb(180,66,97) |
|
pink |
|
|
| mff blue |
rgb(95,118,168) |
|
blue |
|
|
| metro |
rgb(157,65,88) |
|
red |
|
|
| sweden yellow |
rgb(221,178,53) |
|
yellow |
|
|
| craft green |
rgb(48,121,75) |
|
green |
|
|
| flumino |
rgb(125,157,71) |
|
lime |
|
|
| white/mint |
rgb(254,254,254) |
rgb(127,162,161) |
white |
sage |
multicolor |
| white/lilac |
rgb(254,254,254) |
rgb(175,147,205) |
white |
purple |
multicolor |
| white/peach |
rgb(254,254,254) |
rgb(197,165,152) |
white |
cream |
multicolor |
| industrial green |
rgb(55,90,86) |
|
green |
|
|
| navy/anthracite melange |
rgb(0,50,84) |
rgb(66,65,63) |
navy |
grey |
multicolor |
| red/anthracite melange |
rgb(191,25,50) |
rgb(66,65,63) |
red |
grey |
multicolor |
| black/anthracite melange |
rgb(0,0,0) |
rgb(66,65,63) |
black |
grey |
multicolor |
| navy/french blue |
rgb(38,43,62) |
rgb(1,126,190) |
navy |
blue |
multicolor |
| abyss blue |
rgb(38,52,79) |
|
navy |
|
|
| cherry berry |
rgb(165,34,66) |
|
red |
|
|
| bright rose |
rgb(203,0,89) |
|
pink |
|
|
| fresh pink |
rgb(205,184,179) |
|
pink |
|
|
| team green |
rgb(52,114,63) |
|
green |
|
|
| club cobolt |
rgb(39,62,104) |
|
blue |
|
|
| smoky green |
rgb(34,59,55) |
|
bottle |
|
|
| washed lichen green |
rgb(132,119,87) |
|
army |
|
|
| washed dream blue |
rgb(127,161,180) |
|
sky |
|
|
| washed pearl blue |
rgb(171,193,202) |
|
sky |
|
|
| washed tawny orange |
rgb(205,125,102) |
|
orange |
|
|
| washed lit peach |
rgb(231,186,167) |
|
orange |
|
|
| washed misty green |
rgb(153,188,166) |
|
mint |
|
|
| washed sierra |
rgb(152,100,76) |
|
brown |
|
|
| driftwood |
rgb(167,158,151) |
|
grey |
|
|
| bronzová |
rgb(150,90,40) |
|
brown |
|
|
| průhledná |
rgb(241,244,251) |
|
white |
|
|
| zlatá |
rgb(217,174,106) |
|
gold yellow |
|
|
| hi vis orange/navy |
rgb(255,101,31) |
rgb(13,13,21) |
orange |
navy |
multicolor |
| grey heather/fluo pink |
rgb(68,68,68) |
rgb(181,59,94) |
grey |
pink |
multicolor |
| petrol melange |
rgb(38,101,118) |
|
turquise |
|
|
| rose melange |
rgb(243,178,184) |
|
pink |
|
|
| black heather |
rgb(51,51,51) |
|
black |
|
|
| dusty turquoise |
rgb(115,134,134) |
|
turquise |
|
|
| peach/vanilla |
rgb(198,155,147) |
rgb(229,224,213) |
orange |
cream |
multicolor |
| pistachio/dusty green |
rgb(168,175,134) |
rgb(147,159,145) |
green |
sage |
multicolor |
| natural stone/biscuit |
rgb(161,151,149) |
rgb(79,44,28) |
cream |
brown |
multicolor |
| vintage denim |
rgb(103,109,135) |
|
blue |
|
|
| vintage light blue |
rgb(202,212,221) |
|
sky |
|
|
| vintage dusky pink |
rgb(217,187,195) |
|
pink |
|
|
| vintage sage green |
rgb(163,170,163) |
|
sage |
|
|
| vintage black |
rgb(72,72,72) |
|
black |
|
|
| optic white |
rgb(248,248,248) |
|
white |
|
|
| soft blue |
rgb(185,204,219) |
|
sky |
|
|
| night blue |
rgb(32,35,54) |
|
navy |
|
|
| hi vis orange/navy |
rgb(249,71,43) |
rgb(29,30,51) |
orange |
navy |
multicolor |
| hi vis orange/royal blue |
rgb(249,71,43) |
rgb(40,29,134) |
orange |
blue |
multicolor |
| hi vis orange/grey |
rgb(249,71,43) |
rgb(86,87,92) |
orange |
grey |
multicolor |
| hi vis orange/black |
rgb(249,71,43) |
rgb(0,0,0) |
orange |
black |
multicolor |
| hi vis yellow/grey |
rgb(215,245,89) |
rgb(86,87,92) |
yellow |
grey |
multicolor |
| paramedic green/hi vis yellow |
rgb(7,60,50) |
rgb(215,245,89) |
bottle |
yellow |
multicolor |
| black/hi vis yellow |
rgb(0,0,0) |
rgb(215,245,89) |
black |
yellow |
multicolor |
| purple/hi vis yellow |
rgb(58,16,94) |
rgb(215,245,89) |
purple |
yellow |
multicolor |
| orange/hi vis yellow |
rgb(223,63,1) |
rgb(215,245,89) |
orange |
yellow |
multicolor |
| red/hi vis yellow |
rgb(195,27,26) |
rgb(215,245,89) |
red |
yellow |
multicolor |
| raspberry/hi vis yellow |
rgb(150,9,108) |
rgb(215,245,89) |
pink |
yellow |
multicolor |
| lime/hi vis yellow |
rgb(84,241,66) |
rgb(215,245,89) |
lime |
yellow |
multicolor |
| royal blue/hi vis yellow |
rgb(40,29,134) |
rgb(215,245,89) |
blue |
yellow |
multicolor |
| navy/hi vis yellow |
rgb(29,30,51) |
rgb(215,245,89) |
navy |
yellow |
multicolor |
| raspberry |
rgb(150,9,108) |
|
pink |
|
|
| paramedic green |
rgb(7,60,50) |
|
bottle |
|
|
| hi vis yellow/hi vis orange |
rgb(224,212,2) |
rgb(249,125,65) |
yellow |
orange |
multicolor |
| hi vis yellow |
rgb(215,245,89) |
|
yellow |
|
|
| hi vis orange |
rgb(249,71,43) |
|
orange |
|
|
| yellow/blue |
rgb(254,232,0) |
rgb(30,65,124) |
yellow |
blue |
multicolor |
| paramedic green/yellow |
rgb(34,62,47) |
rgb(254,232,0) |
bottle |
yellow |
multicolor |
| yellow/orange |
rgb(248,229,2) |
rgb(226,91,11) |
yellow |
orange |
multicolor |
| cameo |
rgb(218,183,163) |
|
cream |
|
|
| formula red |
rgb(179,10,33) |
|
red |
|
|
| sunset melange |
rgb(247,154,132) |
|
orange |
|
|
| neon mandarine |
rgb(252,160,101) |
|
orange |
|
|
| antique silver |
rgb(135,135,135) |
|
grey |
|
|
| light anthracite |
rgb(66,68,72) |
|
grey |
|
|
| military |
rgb(78,76,54) |
|
army |
|
|
| anthracite melange |
rgb(35,35,35) |
|
dark |
|
|
| marina blue |
rgb(41,59,73) |
|
navy |
|
|
| king blue |
rgb(14,97,139) |
|
blue |
|
|
| scarlet red |
rgb(229,34,30) |
|
red |
|
|
| black opal |
rgb(37,37,37) |
|
black |
|
|
| nautical navy |
rgb(32,44,70) |
|
navy |
|
|
| powder pink |
rgb(252,231,230) |
|
pink |
|
|
| bubble gum pink |
rgb(255,163,214) |
|
pink |
|
|
| blue mint |
rgb(189,218,216) |
|
mint |
|
|
| wild green/black |
rgb(107,202,98) |
rgb(0,0,0) |
lime |
black |
multicolor |
| ink |
rgb(42,54,68) |
|
navy |
|
|
| sunshine |
rgb(235,229,177) |
|
yellow |
|
|
| moss |
rgb(109,104,85) |
|
army |
|
|
| ecru |
rgb(237,230,220) |
|
cream |
|
|
| aubergine |
rgb(68,54,77) |
|
purple |
|
|
| dusty blue/sandstone |
rgb(52,83,104) |
rgb(232,223,214) |
turquise |
cream |
multicolor |
| smoky green/sandstone |
rgb(48,78,76) |
rgb(232,223,214) |
bottle |
cream |
multicolor |
| raw |
rgb(224,214,204) |
|
cream |
|
|
| dusty indigo |
rgb(103,146,178) |
|
blue |
|
|
| dusty mint |
rgb(154,200,171) |
|
sage |
|
|
| beryl blue |
rgb(157,225,234) |
|
sky |
|
|
| dark blue |
rgb(36,49,91) |
|
navy |
|
|
| vintage blue |
rgb(121,137,171) |
|
blue |
|
|
| viola blue |
rgb(178,193,234) |
|
sky |
|
|
| intense blue |
rgb(1,116,203) |
|
blue |
|
|
| powder blue |
rgb(165,186,217) |
|
sky |
|
|
| baltic blue |
rgb(154,200,226) |
|
sky |
|
|
| purple night |
rgb(78,58,86) |
|
purple |
|
|
| plum purple |
rgb(81,49,62) |
|
purple |
|
|
| cherry |
rgb(105,45,57) |
|
burgundy |
|
|
| dusk rose |
rgb(207,176,171) |
|
pink |
|
|
| hibiscus pink |
rgb(230,73,118) |
|
pink |
|
|
| city red |
rgb(224,21,51) |
|
red |
|
|
| forgotten orange |
rgb(216,129,52) |
|
orange |
|
|
| pale moss |
rgb(218,192,117) |
|
yellow |
|
|
| soft yellow |
rgb(225,214,184) |
|
yellow |
|
|
| soft salvia |
rgb(186,188,166) |
|
sage |
|
|
| retro green |
rgb(0,120,129) |
|
turquise |
|
|
| bark |
rgb(144,80,68) |
|
brown |
|
|
| union beige |
rgb(200,166,129) |
|
cream |
|
|
| ready for dye |
rgb(226,223,216) |
|
cream |
|
|
| wet sand |
rgb(204,188,172) |
|
cream |
|
|
| blanc white |
rgb(228,227,222) |
|
white |
|
|
| dark shadow |
rgb(94,92,95) |
|
dark |
|
|
| magnet |
rgb(103,93,94) |
|
grey |
|
|
| forest night |
rgb(38,44,34) |
|
bottle |
|
|
| redwood |
rgb(97,60,51) |
|
brown |
|
|
| dark marine/natural |
rgb(28,69,75) |
rgb(239,221,187) |
bottle |
cream |
multicolor |
| rose/natural |
rgb(165,115,106) |
rgb(239,221,187) |
pink |
cream |
multicolor |
| oxblood/natural |
rgb(50,20,28) |
rgb(239,221,187) |
brown |
cream |
multicolor |
| pumpkin/natural |
rgb(131,53,14) |
rgb(239,221,187) |
orange |
cream |
multicolor |
| natural/peach |
rgb(239,221,187) |
|
cream |
orange |
multicolor |
| natural/dusty green |
rgb(239,221,187) |
rgb(133,149,138) |
cream |
sage |
multicolor |
| natural/caramel |
rgb(239,221,187) |
rgb(131,101,67) |
cream |
brown |
multicolor |
| natural/blue grey |
rgb(239,221,187) |
rgb(113,123,132) |
cream |
grey |
multicolor |
| mango sorbet |
rgb(251,146,91) |
|
orange |
|
|
| raspberry ripple |
rgb(226,110,171) |
|
pink |
|
|
| blueberry swirl |
rgb(182,153,211) |
|
purple |
|
|
| graphite/white |
rgb(75,76,81) |
rgb(254,254,254) |
dark |
white |
multicolor |
| riviera |
rgb(8,108,184) |
|
blue |
|
|
| light red |
rgb(211,32,62) |
|
red |
|
|
| linen |
rgb(219,200,183) |
|
cream |
|
|
| cactus green |
rgb(82,134,98) |
|
green |
|
|
| natural clay |
rgb(119,110,103) |
|
grey |
|
|
| pina colada |
rgb(237,234,189) |
|
cream |
|
|
| platinum grey |
rgb(154,146,144) |
|
grey |
|
|
| rainforest green |
rgb(5,70,48) |
|
bottle |
|
|
| milky blue |
rgb(175,195,206) |
|
sky |
|
|
| sandstone |
rgb(236,227,218) |
|
cream |
|
|
| mustang/beige |
rgb(92,59,50) |
rgb(212,206,194) |
brown |
cream |
multicolor |
| pacific pearl |
rgb(144,173,213) |
|
sky |
|
|
| waterfall |
rgb(106,152,167) |
|
turquise |
|
|
| beige/green |
rgb(212,206,194) |
rgb(10,124,75) |
cream |
green |
multicolor |
| mars red |
rgb(222,51,67) |
|
red |
|
|
| moss green/white |
rgb(105,96,63) |
rgb(254,254,254) |
army |
white |
multicolor |
| putty |
rgb(217,211,199) |
|
cream |
|
|
| folk pink |
rgb(145,28,44) |
|
red |
|
|
| folk red |
rgb(154,25,47) |
|
red |
|
|
| legend |
rgb(228,209,192) |
|
cream |
|
|
| capuccino |
rgb(62,34,23) |
|
brown |
|
|
| mushroom |
rgb(117,111,99) |
|
cream |
|
|
| dark navy/white |
rgb(43,49,65) |
rgb(254,254,254) |
navy |
white |
multicolor |
| gold/white |
rgb(210,193,165) |
rgb(254,254,254) |
gold yellow |
white |
multicolor |
| blue/beige |
rgb(77,111,172) |
rgb(219,204,194) |
blue |
cream |
multicolor |
| mustang/beige |
rgb(108,75,66) |
rgb(219,204,194) |
brown |
cream |
multicolor |
| ocean blue |
rgb(70,130,184) |
|
sky |
|
|
| cement |
rgb(217,216,211) |
|
cream |
|
|
| cyan |
rgb(39,180,234) |
|
sky |
|
|
| fuchsia/slate grey |
rgb(211,39,99) |
rgb(86,86,86) |
pink |
grey |
multicolor |
| navy/slate grey |
rgb(0,21,44) |
rgb(86,86,86) |
navy |
grey |
multicolor |
| black/magenta |
rgb(0,0,0) |
rgb(148,30,98) |
black |
magenta |
multicolor |
| black/burnt lime |
rgb(0,0,0) |
rgb(147,169,37) |
black |
lime |
multicolor |
| black/euroblue |
rgb(0,0,0) |
rgb(85,105,174) |
black |
blue |
multicolor |
| burnt lime |
rgb(147,169,37) |
|
lime |
|
|
| bottle green/beige |
rgb(28,68,60) |
rgb(219,204,194) |
bottle |
cream |
multicolor |
| dark grey/beige |
rgb(65,65,65) |
rgb(219,204,194) |
dark |
cream |
multicolor |
| burgundy/beige |
rgb(90,24,38) |
rgb(219,204,194) |
burgundy |
cream |
multicolor |
| euroblue |
rgb(85,105,174) |
|
blue |
|
|
| rainbow |
rgb(222,75,119) |
rgb(11,109,144) |
|
|
multicolor |
| slate grey |
rgb(86,86,86) |
|
grey |
|
|
| burbon vanilla |
rgb(239,217,176) |
|
cream |
|
|
| neon mandarine |
rgb(252,149,90) |
|
orange |
|
|
| lime punch |
rgb(202,204,6) |
|
lime |
green |
|
| grass green |
rgb(133,175,99) |
|
green |
|
|
| frost |
rgb(212,235,225) |
|
sky |
sage |
|
| midnight blue |
rgb(28,54,91) |
|
blue |
navy |
|
| snorkel blue |
rgb(1,98,167) |
|
blue |
|
|
| rhododendron |
rgb(113,48,68) |
|
burgundy |
dark |
|
| fuchsia red |
rgb(163,54,103) |
|
burgundy |
|
|
| tangerine orange |
rgb(243,140,22) |
|
orange |
|
|
| marlboro red |
rgb(150,27,48) |
|
red |
burgundy |
|
| garnet |
rgb(94,6,44) |
|
burgundy |
dark |
|
| coffee |
rgb(71,55,55) |
|
brown |
dark |
|
| ice gray |
rgb(201,194,186) |
|
grey |
|
|
| ash melange |
rgb(196,197,199) |
|
grey |
|
|
| castor gray |
rgb(85,92,85) |
|
grey |
dark |
|
| ebony gray |
rgb(54,54,54) |
|
grey |
dark |
|
žlutá
|
rgb(255,231,0)
|
|
yellow
|
|
|
| nebesky modrá |
rgb(32,152,199) |
|
turquise |
|
|
| olive/camouflage |
rgb(95,98,83) |
rgb(0,0,0) |
army |
dark |
multicolor |
| dark melange/royal |
rgb(170,174,176) |
rgb(39,60,118) |
dark |
blue |
multicolor |
| dark melange/red |
rgb(170,174,176) |
rgb(195,35,41) |
dark |
red |
multicolor |
| dark melange/yellow |
rgb(170,174,176) |
rgb(247,221,10) |
dark |
yellow |
multicolor |
| dark melange/green |
rgb(170,174,176) |
rgb(84,173,117) |
dark |
green |
multicolor |
| dark melange/black |
rgb(170,174,176) |
rgb(0,0,0) |
dark |
black |
multicolor |
| iron grey/green |
rgb(53,58,64) |
rgb(111,192,66) |
dark |
green |
multicolor |
| olive melange/black |
rgb(94,92,76) |
rgb(0,0,0) |
army |
black |
multicolor |
| nautic blue/navy |
rgb(48,95,223) |
rgb(0,50,84) |
blue |
navy |
multicolor |
| green/navy |
rgb(84,173,117) |
rgb(0,50,84) |
green |
navy |
multicolor |
| iron grey/red |
rgb(53,58,64) |
rgb(195,35,41) |
dark |
red |
multicolor |
| silver melange/graphite |
rgb(184,178,166) |
rgb(76,86,92) |
grey |
dark |
multicolor |
| cobalt/silver |
rgb(0,136,204) |
rgb(156,155,167) |
blue |
grey |
multicolor |
| light red/white |
rgb(208,0,68) |
rgb(254,254,254) |
red |
white |
multicolor |
| nautic blue/white |
rgb(48,95,223) |
rgb(254,254,254) |
blue |
white |
multicolor |
| irish green/white |
rgb(33,156,114) |
rgb(254,254,254) |
green |
white |
multicolor |
| light melange/black |
rgb(180,183,190) |
rgb(0,0,0) |
grey |
black |
multicolor |
| dark melange/black |
rgb(66,65,67) |
rgb(0,0,0) |
dark |
black |
multicolor |
| surf blue/graphite grey |
rgb(4,182,220) |
rgb(82,80,82) |
blue |
dark |
multicolor |
| airforce blue/graphite grey |
rgb(57,93,113) |
rgb(82,80,82) |
blue |
dark |
multicolor |
| sky blue/french navy |
rgb(141,191,228) |
rgb(20,44,68) |
blue |
navy |
multicolor |
| fuchsia/graphite grey |
rgb(217,48,123) |
rgb(82,80,82) |
pink |
dark |
multicolor |
| classic pink/graphite grey |
rgb(248,176,204) |
rgb(82,80,82) |
pink |
dark |
multicolor |
| yellow/graphite grey |
rgb(247,221,10) |
rgb(82,80,82) |
yellow |
dark |
multicolor |
| mint green/light grey |
rgb(111,189,153) |
rgb(191,212,239) |
sage |
grey |
multicolor |
| lime green/graphite grey |
rgb(142,197,66) |
rgb(82,80,82) |
lime |
dark |
multicolor |
| electric blue/white |
rgb(17,30,135) |
rgb(254,254,254) |
blue |
white |
multicolor |
| light grey/graphite grey |
rgb(196,200,201) |
rgb(82,80,82) |
grey |
dark |
multicolor |
| pink melange/off white |
rgb(241,149,171) |
rgb(255,255,255) |
pink |
white |
multicolor |
| royal melange/red |
rgb(53,68,150) |
rgb(195,35,41) |
blue |
red |
multicolor |
| kiwi melange/royal |
rgb(186,193,98) |
rgb(39,60,118) |
lime |
blue |
multicolor |
| light grey melange/red |
rgb(176,178,189) |
rgb(195,35,41) |
grey |
red |
multicolor |
| dark grey melange/silver |
rgb(55,58,73) |
rgb(156,155,167) |
dark |
grey |
multicolor |
| red melange/anthracite melange |
rgb(186,60,71) |
rgb(76,86,92) |
red |
dark |
multicolor |
| deep green/black |
rgb(88,96,83) |
|
army |
black |
multicolor |
| clay/black |
rgb(155,136,122) |
rgb(0,0,0) |
brown |
black |
multicolor |
| army/dark army |
rgb(59,58,37) |
rgb(56,43,24) |
army |
|
|
| shear beige/beige |
rgb(248,233,212) |
rgb(220,209,191) |
cream |
|
|
| carbon grey/black |
rgb(31,30,28) |
rgb(0,0,0) |
dark |
black |
multicolor |
| fir green |
rgb(38,71,50) |
|
bottle |
|
|
| charcoal grey |
rgb(44,43,51) |
|
dark |
|
|
| camel heather |
rgb(187,133,97) |
|
brown |
|
|
| space grey |
rgb(127,130,137) |
|
grey |
|
|
| skydiver |
rgb(24,114,183) |
|
blue |
|
|
| convoy grey |
rgb(86,83,94) |
|
grey |
|
|
| titanium |
rgb(68,63,70) |
|
dark |
|
|
| wet sand/black |
rgb(161,129,104) |
rgb(0,0,0) |
brown |
black |
multicolor |
| marine splash |
rgb(29,29,33) |
rgb(115,157,155) |
black |
turquise |
multicolor |
| alpine blues |
rgb(37,60,134) |
rgb(51,96,99) |
blue |
bottle |
multicolor |
| chilli blues |
rgb(52,107,177) |
rgb(174,43,52) |
blue |
red |
multicolor |
| winter berries |
rgb(106,30,69) |
rgb(81,129,135) |
burgundy |
turquise |
multicolor |
| lavender fizz |
rgb(161,152,195) |
rgb(31,42,64) |
purple |
navy |
multicolor |
| milkshake mix |
rgb(209,199,189) |
rgb(221,168,149) |
cream |
orange |
multicolor |
| crackling campfire |
rgb(46,52,74) |
rgb(178,46,41) |
dark |
red |
multicolor |
| cherry sherbet |
rgb(74,22,38) |
rgb(190,47,45) |
burgundy |
orange |
multicolor |
| retro blues |
rgb(59,63,73) |
rgb(197,106,54) |
dark |
orange |
multicolor |
| morning frost |
rgb(54,64,83) |
rgb(227,171,0) |
navy |
gold yellow |
multicolor |
| watermelon breeze |
rgb(0,0,0) |
rgb(172,85,92) |
black |
red |
multicolor |
| autumn moss |
rgb(0,0,0) |
rgb(124,125,84) |
black |
green |
multicolor |
| black jacks |
rgb(0,0,0) |
rgb(170,40,76) |
black |
red |
multicolor |
| electric grey |
rgb(128,132,133) |
rgb(195,221,102) |
grey |
lime |
multicolor |
| artic dawn |
rgb(0,0,0) |
rgb(254,254,254) |
black |
white |
multicolor |
| military green/black |
rgb(56,52,26) |
rgb(0,0,0) |
army |
black |
multicolor |
| oatmeal |
rgb(223,221,211) |
|
cream |
|
|
| rocky peaks |
rgb(42,62,91) |
rgb(223,227,228) |
navy |
white |
multicolor |
| glacier peaks |
rgb(143,192,227) |
rgb(245,246,250) |
sky |
white |
multicolor |
| desert peaks |
rgb(48,31,48) |
rgb(218,156,55) |
purple |
cream |
multicolor |
| alpine peaks |
rgb(37,55,41) |
rgb(240,236,187) |
bottle |
cream |
multicolor |
| pebble |
rgb(200,185,158) |
|
cream |
|
|
| olive green/stone |
rgb(70,72,61) |
rgb(214,201,184) |
army |
cream |
multicolor |
| french navy/sapphire |
rgb(2,38,88) |
rgb(2,87,152) |
navy |
|
multicolor |
| french navy/orange |
rgb(2,38,88) |
rgb(250,117,0) |
navy |
orange |
multicolor |
| black/kelly green |
rgb(0,0,0) |
rgb(21,135,81) |
black |
green |
multicolor |
| true pink/classic red |
rgb(241,106,149) |
rgb(173,15,53) |
pink |
red |
multicolor |
| vanilla/biscuit |
rgb(227,216,195) |
rgb(221,173,117) |
cream |
brown |
multicolor |
| natural stone/dusty blue |
rgb(204,192,182) |
rgb(155,190,212) |
grey |
blue |
multicolor |
| black/soft white |
rgb(0,0,0) |
rgb(251,250,245) |
black |
white |
multicolor |
| biscuit |
rgb(221,173,117) |
|
brown |
|
|
| oxford navy/white |
rgb(0,26,70) |
rgb(254,254,254) |
navy |
white |
multicolor |
| oatmeal/white |
rgb(223,221,211) |
rgb(254,254,254) |
cream |
white |
multicolor |
| ash/white |
rgb(174,178,179) |
rgb(254,254,254) |
grey |
white |
multicolor |
| desert sand/black |
rgb(215,204,178) |
rgb(0,0,0) |
cream |
black |
multicolor |
| teal |
rgb(2,97,120) |
|
turquise |
|
|
| heather surf |
rgb(112,211,238) |
|
blue |
|
|
| heather oatmeal |
rgb(192,166,157) |
|
brown |
|
|
| fluorescent green |
rgb(150,196,34) |
|
lime |
|
|
| almond |
rgb(222,215,197) |
|
cream |
|
|
| antique grey |
rgb(110,109,111) |
|
grey |
|
|
| soft white |
rgb(251,250,245) |
|
white |
|
|
| granite |
rgb(157,160,167) |
|
grey |
|
|
| airforce blue/black |
rgb(58,90,104) |
rgb(0,0,0) |
turquise |
black |
multicolor |
| olive green/black |
rgb(80,83,65) |
rgb(0,0,0) |
army |
black |
multicolor |
| strawberry haze |
rgb(224,187,168) |
|
pink |
|
|
| espresso haze |
rgb(163,125,85) |
|
brown |
|
|
| cloudy haze |
rgb(211,211,211) |
|
grey |
|
|
| midnight haze |
rgb(10,10,10) |
|
dark |
|
|
| oxford navy/black |
rgb(0,26,70) |
rgb(0,0,0) |
navy |
black |
multicolor |
| military green |
rgb(57,83,60) |
rgb(0,0,0) |
army |
black |
multicolor |
| walnut/black |
rgb(83,55,37) |
rgb(0,0,0) |
brown |
black |
multicolor |
| biscuit/black |
rgb(156,128,90) |
rgb(0,0,0) |
brown |
black |
multicolor |
| oatmeal/black |
rgb(232,220,196) |
rgb(0,0,0) |
cream |
black |
multicolor |
| graphite grey/black |
rgb(64,66,69) |
rgb(0,0,0) |
dark |
black |
multicolor |
| dark graphite |
rgb(57,57,63) |
|
dark |
|
|
| bright lavender |
rgb(176,152,197) |
|
purple |
|
|
| french navy/soft white |
rgb(2,38,88) |
rgb(251,250,245) |
navy |
white |
multicolor |
| black/graphite grey |
rgb(0,0,0) |
rgb(99,99,103) |
black |
dark |
multicolor |
| soft white/french navy |
rgb(251,250,245) |
rgb(2,38,88) |
white |
navy |
multicolor |
| soft white/classic red |
rgb(251,250,245) |
rgb(173,23,68) |
white |
red |
multicolor |
| navy fleck |
rgb(47,51,64) |
|
navy |
|
|
| oatmeal fleck |
rgb(185,174,158) |
|
cream |
|
|
| light grey fleck |
rgb(178,178,178) |
|
grey |
|
|
| sherbet dip |
rgb(244,246,245) |
rgb(26,95,92) |
white |
bottle |
multicolor |
| forager fusion |
rgb(187,191,194) |
rgb(212,146,64) |
grey |
orange |
multicolor |
| liquorice zing |
rgb(34,31,32) |
rgb(170,192,23) |
dark |
lime |
multicolor |
| black/graphite grey |
rgb(0,0,0) |
rgb(99,99,103) |
black |
dark |
multicolor |
| teal/french navy |
rgb(71,132,149) |
rgb(2,38,88) |
turquise |
navy |
multicolor |
| dusky pink/off white |
rgb(212,151,168) |
rgb(248,240,227) |
pink |
white |
multicolor |
| french navy/light grey |
rgb(2,38,88) |
rgb(198,197,199) |
navy |
grey |
multicolor |
| fuchsia/off white |
rgb(191,42,128) |
rgb(248,240,227) |
pink |
white |
multicolor |
| bright red/off white |
rgb(255,22,12) |
rgb(248,240,227) |
red |
white |
multicolor |
| french navy/stone |
rgb(2,38,88) |
rgb(214,201,184) |
navy |
cream |
multicolor |
| graphite grey/black |
rgb(99,99,103) |
rgb(0,0,0) |
dark |
black |
multicolor |
| black/flucorescent pink |
rgb(0,0,0) |
rgb(255,112,197) |
black |
pink |
multicolor |
| black/fluorescent orange |
rgb(0,0,0) |
rgb(255,123,25) |
black |
orange |
multicolor |
| black/fluorescent yellow |
rgb(0,0,0) |
rgb(255,243,0) |
black |
yellow |
multicolor |
| black/stone |
rgb(0,0,0) |
rgb(214,201,184) |
black |
cream |
multicolor |
| blue steel |
rgb(177,178,174) |
rgb(36,38,76) |
grey |
blue |
multicolor |
| blueberry cheesecake |
rgb(242,241,237) |
rgb(192,178,214) |
white |
purple |
multicolor |
| dijon blue |
rgb(34,42,68) |
rgb(197,153,24) |
navy |
gold yellow |
multicolor |
| marshmallow sundae |
rgb(34,42,68) |
rgb(188,153,139) |
navy |
cream |
multicolor |
| black cherry |
rgb(0,0,0) |
rgb(164,18,37) |
black |
red |
multicolor |
| french navy/fuchsia |
rgb(2,38,88) |
rgb(157,40,89) |
navy |
pink |
multicolor |
| off white/french navy |
rgb(248,240,227) |
rgb(2,38,88) |
white |
navy |
multicolor |
| off white/bright red |
rgb(248,240,227) |
rgb(255,22,12) |
white |
red |
multicolor |
| black/bright royal |
rgb(0,0,0) |
rgb(6,33,177) |
black |
blue |
multicolor |
| black/bright red |
rgb(0,0,0) |
rgb(255,22,12) |
black |
red |
multicolor |
| dusky pink |
rgb(212,151,168) |
|
pink |
|
|
| emerald/soft white |
rgb(62,140,145) |
rgb(251,250,245) |
bottle |
white |
multicolor |
| oxford navy/fire red |
rgb(48,50,86) |
rgb(229,54,33) |
navy |
red |
multicolor |
| oxford navy/mustard |
rgb(48,50,86) |
rgb(171,123,28) |
navy |
gold yellow |
multicolor |
| azure blue/oxford navy |
rgb(5,123,194) |
rgb(48,50,86) |
blue |
navy |
multicolor |
| classic red/true pink |
rgb(173,23,68) |
rgb(232,146,197) |
classic |
pink |
multicolor |
| orange/graphite grey |
rgb(224,80,34) |
rgb(80,82,80) |
orange |
grey |
multicolor |
| light grey/citron |
rgb(198,197,199) |
rgb(204,211,12) |
grey |
yellow |
multicolor |
| graphity grey/blush |
rgb(80,82,80) |
rgb(243,157,147) |
grey |
pink |
multicolor |
| almond marl |
rgb(229,222,204) |
|
cream |
|
|
| grey marl |
rgb(177,177,177) |
|
grey |
|
|
| black marl |
rgb(40,40,40) |
|
black |
|
|
| smoke grey |
rgb(102,102,102) |
|
grey |
|
|
| vanilla |
rgb(234,223,195) |
|
cream |
|
|
| cloud grey |
rgb(238,238,238) |
|
grey |
|
|
| granite |
rgb(133,135,139) |
|
grey |
|
|
| classic red/white |
rgb(208,3,63) |
rgb(254,254,254) |
red |
white |
multicolor |
| marine green |
rgb(73,92,86) |
|
green |
|
|
| pink melange/anthracite melange |
rgb(241,149,171) |
rgb(76,86,92) |
pink |
dark |
multicolor |
| royal melange/anthracite melange |
rgb(0,97,161) |
rgb(76,86,92) |
blue |
dark |
multicolor |
| kiwi melange/anthracite melange |
rgb(180,190,77) |
rgb(76,86,92) |
lime |
dark |
multicolor |
| light melange/anthracite melange |
rgb(181,179,179) |
rgb(76,86,92) |
grey |
dark |
multicolor |
| grey melange/anthracite melange |
rgb(155,154,154) |
rgb(76,86,92) |
dark |
dark |
multicolor |
| navy/royal melange |
rgb(0,50,84) |
rgb(0,97,161) |
navy |
blue |
multicolor |
| black/red melange |
rgb(0,0,0) |
rgb(189,43,11) |
black |
red |
multicolor |
| black/olive melange |
rgb(0,0,0) |
rgb(140,135,82) |
black |
army |
multicolor |
| black/carbon melange |
rgb(0,0,0) |
rgb(76,86,92) |
black |
dark |
multicolor |
| blue/navy |
rgb(105,164,217) |
rgb(0,50,84) |
blue |
navy |
multicolor |
| electric orange |
rgb(232,119,34) |
|
orange |
|
|
| navy/turquoise |
rgb(0,50,84) |
rgb(0,166,208) |
navy |
turquise |
multicolor |
| dark green/orange |
rgb(0,86,67) |
rgb(251,120,37) |
bottle |
orange |
multicolor |
| brown/stone |
rgb(95,72,50) |
rgb(245,237,208) |
brown |
cream |
multicolor |
| stone/black |
rgb(245,237,208) |
rgb(0,0,0) |
cream |
black |
multicolor |
| carbon/black |
rgb(102,112,125) |
rgb(0,0,0) |
dark |
black |
multicolor |
| indian red |
rgb(178,9,51) |
|
red |
|
|
| terra spice |
rgb(193,198,200) |
|
brown |
|
|
| silver grey |
rgb(202,97,47) |
|
grey |
|
|
| faded denim |
rgb(155,143,139) |
|
denim |
|
|
| taupe |
rgb(72,84,112) |
|
brown |
|
|
| orient red |
rgb(193,10,39) |
|
red |
|
|
| anthracite/light blue |
rgb(81,80,77) |
rgb(149,153,158) |
dark |
sky |
multicolor |
| anthracite/light grey |
rgb(81,80,77) |
rgb(191,212,239) |
dark |
grey |
multicolor |
| petrol/mint |
rgb(120,161,169) |
rgb(182,228,217) |
turquise |
sage |
multicolor |
| navy/gold |
rgb(63,73,101) |
rgb(191,212,239) |
navy |
gold yellow |
multicolor |
| brown/cream |
rgb(117,60,42) |
rgb(222,211,176) |
brown |
cream |
multicolor |
| anthracite/turquoise |
rgb(81,80,77) |
rgb(0,130,182) |
dark |
turquise |
multicolor |
| sea green |
rgb(157,211,207) |
|
turquise |
|
|
| bandera red |
rgb(204,9,53) |
|
red |
|
|
| milky beige |
rgb(235,230,214) |
|
cream |
|
|
| white snow |
rgb(255,255,255) |
|
white |
|
|
| salmon |
rgb(245,195,202) |
|
pink |
|
|
| light olive |
rgb(233,242,195) |
|
sage |
|
|
| oasis green |
rgb(0,170,146) |
|
bottle |
|
|
| lagooon |
rgb(9,121,136) |
|
turquise |
|
|
| poseidon |
rgb(0,88,94) |
|
navy |
|
|
| reflex blue |
rgb(56,72,131) |
|
blue |
|
|
| fox |
rgb(228,113,39) |
|
orange |
|
|
| skyline |
rgb(88,201,212) |
|
turquise |
|
|
| sea shimmer |
rgb(21,126,160) |
|
blue |
|
|
| blackberry |
rgb(163,87,118) |
|
burgundy |
|
|
| salamander |
rgb(226,168,41) |
|
gold yellow |
|
| avocado |
rgb(186,188,114) |
|
sage |
|
|
| clover |
rgb(72,125,73) |
|
bottle |
|
|
| tibet |
rgb(206,186,168) |
|
cream |
|
|
| ivory |
rgb(242,240,235) |
|
cream |
|
|
| shadow |
rgb(181,186,182) |
|
grey |
|
|
| pepplestone |
rgb(149,139,132) |
|
brown |
|
|
| azure aqua |
rgb(4,128,238) |
|
blue |
|
|
| petrol/white |
rgb(120,161,169) |
rgb(254,254,254) |
sage |
white |
multicolor |
| blue/white |
rgb(107,150,222) |
rgb(254,254,254) |
blue |
white |
multicolor |
| purple/white |
rgb(151,122,207) |
rgb(254,254,254) |
purple |
white |
multicolor |
| mint/white |
rgb(182,228,217) |
rgb(254,254,254) |
sage |
white |
multicolor |
| olive green/white |
rgb(102,110,83) |
rgb(254,254,254) |
army |
white |
multicolor |
| anthracite/white |
rgb(81,80,77) |
rgb(254,254,254) |
dark |
white |
multicolor |
| white/grey |
rgb(254,254,254) |
rgb(116,118,121) |
white |
grey |
multicolor |
| marine blue |
rgb(54,55,86) |
|
navy |
|
|
| ruby |
rgb(174,14,54) |
|
burgundy |
|
|
| oceanic |
rgb(0,140,149) |
|
turquise |
|
|
| iris |
rgb(197,180,227) |
|
purple |
|
|
| lollipop |
rgb(152,115,172) |
|
purple |
|
|
| prim rose |
rgb(226,69,133) |
|
purple |
|
|
| electric orange |
rgb(232,119,34) |
|
orange |
|
|
| electric yellow |
rgb(240,236,116) |
|
yellow |
|
|
| meadow green |
rgb(181,191,80) |
|
lime |
|
|
| white/grey |
rgb(254,254,254) |
rgb(128,129,125) |
white |
grey |
multicolor |
| air blue |
rgb(97,170,177) |
|
turquise |
|
|
| purple turquoise |
rgb(0,135,153) |
|
purple |
turquise |
multicolor |
| spiced coral |
rgb(215,92,93) |
|
orange |
|
|
| green glow |
rgb(176,201,150) |
|
lime |
|
|
| light blue denim |
rgb(220,234,243) |
|
denim |
|
|
| black/grey denim |
rgb(54,56,56) |
rgb(128,129,125) |
black |
dark |
multicolor |
| blaze orange |
rgb(252,130,28) |
|
orange |
|
|
| powder yellow |
rgb(239,236,210) |
|
cream |
|
|
| white sand |
rgb(225,216,206) |
|
cream |
|
|
| safety orange |
rgb(255,143,108) |
|
orange |
|
|
| camo tree |
rgb(107,80,71) |
rgb(138,131,102) |
army |
|
|
| ocher |
rgb(210,167,124) |
|
cream |
|
|
| highlander |
rgb(112,90,65) |
rgb(125,98,89) |
army |
|
|
| raid |
rgb(86,84,89) |
rgb(167,164,171) |
grey |
|
|
| typhon |
rgb(53,52,57) |
rgb(99,102,116) |
dark |
|
|
| wraith |
rgb(215,211,208) |
rgb(240,239,235) |
grey |
|
|
| red/royal |
rgb(191,25,50) |
rgb(39,60,118) |
red |
blue |
multicolor |
| multicam khaki |
rgb(158,150,112) |
rgb(184,169,132) |
army |
|
|
| pine green |
rgb(121,122,108) |
|
army |
|
|
| green camouflage |
rgb(78,92,48) |
rgb(152,163,113) |
army |
|
|
| arid/brown |
rgb(184,148,125) |
rgb(78,64,59) |
army |
brown |
multicolor |
| multicam arid/tan |
rgb(184,148,125) |
rgb(102,77,59) |
army |
brown |
multicolor |
| multicam alpina |
rgb(221,220,215) |
rgb(197,198,193) |
white |
grey |
multicolor |
| blue melange/charcoal melange |
rgb(122,119,126) |
rgb(101,96,105) |
blue |
dark |
multicolor |
| stone grey |
rgb(119,126,144) |
|
grey |
|
|
| burnt olive |
rgb(111,91,64) |
|
army |
|
|
| pale grey |
rgb(160,143,135) |
|
army |
|
|
| ballad blue |
rgb(191,202,214) |
|
sky |
|
|
| prism pink |
rgb(240,161,191) |
|
pink |
|
|
| sea blue |
rgb(63,82,119) |
|
blue |
|
|
| maroon/white |
rgb(88,54,61) |
rgb(254,254,254) |
burgundy |
white |
multicolor |
| chick navy |
rgb(42,47,63) |
|
navy |
|
|
| chick red |
rgb(193,24,33) |
|
red |
|
|
| chick anthracite |
rgb(73,72,76) |
|
dark |
|
|
| chick black |
rgb(80,78,92) |
|
black |
|
|
| chic pure white |
rgb(246,246,245) |
|
white |
|
|
| heather forest |
rgb(0,43,35) |
|
bottle |
|
|
| heather dark grey |
rgb(57,55,60) |
|
dark |
|
|
| pixel coral |
rgb(235,93,62) |
|
orange |
|
|
| pacific green |
rgb(0,161,131) |
|
green |
|
|
| denim/burgundy |
rgb(35,46,68) |
rgb(97,28,56) |
denim |
burgundy |
multicolor |
| denim/navy |
|
|
denim |
navy |
multicolor |
| denim/heather grey |
|
|
denim |
grey |
multicolor |
| heather grey/ryoal |
rgb(121,128,130) |
rgb(45,55,116) |
grey |
blue |
multicolor |
| slate blue |
rgb(121,146,187) |
|
blue |
|
|
| spruce |
rgb(49,73,59) |
|
bottle |
|
|
| steel blue/silver |
rgb(40,114,159) |
rgb(181,179,184) |
blue |
grey |
multicolor |
| batic orange/white |
rgb(234,215,193) |
rgb(254,254,254) |
white |
orange |
multicolor |
| green camo/black |
rgb(95,65,63) |
rgb(0,0,0) |
army |
black |
multicolor |
| dark navy/navy |
rgb(46,47,54) |
rgb(53,58,76) |
navy |
|
|
| dark cobalt/lobl |
rgb(25,81,144) |
rgb(15,95,154) |
blue |
navy |
multicolor |
| brown/khaki |
rgb(78,64,59) |
rgb(159,141,124) |
brown |
|
|
| chocolate chip/greyish brown |
rgb(91,81,73) |
rgb(72,65,59) |
army |
grey |
multicolor |
| carolina blue/white |
rgb(146,181,217) |
rgb(254,254,254) |
blue |
white |
multicolor |
| brown/white |
rgb(78,64,59) |
rgb(254,254,254) |
brown |
white |
multicolor |
| blue raw |
rgb(101,110,139) |
|
denim |
|
|
| black raw |
rgb(61,56,52) |
|
black |
|
|
| greyish navy |
rgb(223,25,28) |
|
navy |
|
|
| greenish grey |
rgb(131,139,150) |
|
grey |
|
|
| delft |
rgb(64,93,115) |
|
blue |
|
|
| chocolate chip |
rgb(91,81,73) |
|
army |
|
|
| mink beige |
rgb(223,213,190) |
|
cream |
|
|
| navy/maroon |
rgb(53,58,76) |
rgb(88,54,61) |
navy |
burgundy |
multicolor |
| royal/orange |
rgb(39,60,118) |
rgb(245,103,51) |
blue |
orange |
multicolor |
| purple/gold |
rgb(79,56,114) |
rgb(255,176,37) |
purple |
gold yellow |
multicolor |
| maroon/black |
rgb(88,54,61) |
rgb(0,0,0) |
burgundy |
black |
multicolor |
| maroon/maroon |
rgb(88,54,61) |
rgb(88,54,61) |
burgundy |
|
|
| multicam tropic |
rgb(82,60,51) |
rgb(131,115,66) |
army |
|
|
| deep olive |
rgb(112,111,72) |
|
army |
|
|
| tan |
rgb(102,77,59) |
|
brown |
|
|
| heather grey/navy |
rgb(164,158,158) |
rgb(53,58,76) |
grey |
navy |
multicolor |
| heather grey/maroon |
rgb(164,158,158) |
rgb(88,54,61) |
grey |
burgundy |
multicolor |
| heather grey/red |
rgb(164,158,158) |
rgb(191,25,50) |
grey |
red |
multicolor |
| heather grey/heather grey |
rgb(164,158,158) |
rgb(164,158,158) |
grey |
|
|
| multicam black |
rgb(61,55,55) |
rgb(48,43,47) |
black |
|
|
| black/teal |
rgb(0,0,0) |
rgb(0,149,198) |
black |
turquise |
multicolor |
| black/purple |
rgb(0,0,0) |
rgb(79,56,114) |
black |
purple |
multicolor |
| black/neon pink |
rgb(0,0,0) |
rgb(238,121,165) |
black |
pink |
multicolor |
| black/neon orange |
rgb(0,0,0) |
rgb(255,141,0) |
black |
orange |
multicolor |
| dark navy/dark navy |
rgb(51,51,54) |
rgb(51,51,54) |
navy |
|
|
| china blue |
rgb(84,100,119) |
|
blue |
|
|
| carolina blue |
rgb(146,181,217) |
|
blue |
|
|
| rose brown |
rgb(129,54,57) |
|
burgundy |
|
|
| spicy orange |
rgb(215,60,38) |
|
orange |
|
|
| fresh green |
rgb(121,199,83) |
|
lime |
|
|
| dark leaf green |
rgb(97,132,91) |
|
sage |
|
|
| pepper green |
rgb(0,125,96) |
|
green |
|
|
| spurce |
rgb(51,77,65) |
|
bottle |
|
|
| coyote brown |
rgb(128,93,36) |
|
brown |
|
|
| curry |
rgb(188,142,72) |
|
brown |
|
|
| dark grey/dark grey |
rgb(46,47,54) |
rgb(50,50,50) |
dark |
|
|
| turquoise/white |
rgb(7,155,205) |
rgb(254,254,254) |
turquise |
white |
multicolor |
| navy/greyish brown |
rgb(53,58,76) |
rgb(72,65,59) |
navy |
grey |
multicolor |
| stel blue/silver |
rgb(40,115,159) |
rgb(156,155,167) |
blue |
grey |
multicolor |
| burgundy/light grey |
rgb(112,47,59) |
rgb(207,207,207) |
burgundy |
grey |
multicolor |
| maroon/grey |
rgb(88,54,61) |
rgb(207,207,207) |
burgundy |
grey |
multicolor |
| rustic orange/khaki |
rgb(227,96,67) |
rgb(159,141,124) |
orange |
brown |
multicolor |
| evegreen/white |
rgb(70,118,96) |
rgb(254,254,254) |
bottle |
white |
multicolor |
| evergreen |
rgb(70,118,96) |
|
bottle |
|
|
| buck |
rgb(83,80,64) |
|
army |
|
|
| buck/white |
rgb(83,80,64) |
rgb(254,254,254) |
army |
white |
multicolor |
| coyote brown/black |
rgb(128,93,36) |
rgb(0,0,0) |
brown |
black |
multicolor |
| moss green/khaki |
rgb(90,82,60) |
rgb(159,141,124) |
army |
brown |
multicolor |
| brown/khaki |
rgb(78,64,59) |
rgb(159,141,124) |
brown |
|
|
| khaki/white |
rgb(159,141,124) |
rgb(254,254,254) |
brown |
white |
multicolor |
| pale khaki/birch |
rgb(186,163,139) |
rgb(202,190,181) |
brown |
cream |
multicolor |
| heather grey/black |
rgb(164,158,158) |
rgb(0,0,0) |
grey |
black |
multicolor |
| heather grey/white |
rgb(164,158,158) |
rgb(254,254,254) |
grey |
white |
multicolor |
| silver/white |
rgb(156,155,167) |
rgb(254,254,254) |
grey |
white |
multicolor |
| charcoal/navy |
rgb(101,100,102) |
rgb(53,58,76) |
dark |
navy |
multicolor |
| charcoal/neon orange |
rgb(101,100,102) |
rgb(255,141,0) |
dark |
orange |
multicolor |
| charcoal/neon green |
rgb(101,100,102) |
rgb(196,216,118) |
dark |
lime |
multicolor |
| black/loden |
rgb(0,0,0) |
rgb(137,125,103) |
black |
brown |
multicolor |
| nature bast |
rgb(48,49,43) |
|
cream |
|
|
| black bast |
rgb(218,184,159) |
|
black |
|
|
| cosmo pink |
rgb(203,51,115) |
|
pink |
|
|
| magic mango |
rgb(243,184,45) |
|
gold yellow |
|
| croissant |
rgb(199,173,150) |
|
cream |
|
|
| black/aqua |
rgb(2,2,2) |
rgb(0,0,0) |
black |
blue |
multicolor |
| black/paisley |
rgb(0,0,0) |
rgb(128,125,125) |
black |
grey |
multicolor |
| black melange/black |
rgb(146,142,141) |
rgb(0,0,0) |
black |
|
|
| grey/grey |
rgb(128,129,125) |
rgb(120,120,120) |
grey |
|
|
| olive camo |
rgb(50,53,53) |
rgb(48,40,45) |
army |
|
|
| black camo |
rgb(24,22,26) |
rgb(42,37,40) |
black |
|
|
| dark heather grey |
rgb(183,173,172) |
rgb(93,83,82) |
dark |
|
|
| silver melange |
rgb(207,208,211) |
rgb(185,185,185) |
grey |
|
|
| heather grey melange |
rgb(129,124,130) |
rgb(135,130,135) |
grey |
|
|
| maroon |
rgb(88,54,61) |
|
burgundy |
|
|
| olive night |
rgb(83,80,64) |
|
army |
|
|
| oak |
rgb(203,193,174) |
|
cream |
|
|
| toffe |
rgb(91,81,73) |
|
brown |
|
|
| wideland |
rgb(156,122,93) |
rgb(68,58,49) |
brown |
black |
multicolor |
| poseidon black |
rgb(164,164,164) |
rgb(116,113,113) |
black |
|
|
| black/heather grey |
rgb(0,0,0) |
rgb(164,158,158) |
black |
grey |
multicolor |
| beige camo |
rgb(213,197,182) |
rgb(226,213,197) |
cream |
|
|
| dark beige camo |
rgb(188,163,143) |
rgb(220,195,173) |
cream |
|
|
| dark camo |
rgb(80,80,80) |
rgb(116,124,136) |
grey |
|
|
| wood camo |
rgb(140,134,101) |
rgb(89,99,85) |
army |
|
|
| multicam |
rgb(124,86,61) |
rgb(158,128,84) |
army |
|
|
| blue tones |
rgb(82,104,119) |
rgb(165,170,176) |
blue |
|
|
| earth tones |
rgb(91,93,101) |
rgb(131,130,135) |
grey |
|
|
| batik lavender |
rgb(223,209,222) |
|
purple |
|
|
| batik mint |
rgb(183,200,190) |
|
sage |
|
|
| silver melange/white |
rgb(187,188,188) |
rgb(254,254,254) |
grey |
white |
multicolor |
| heather grey/navy |
rgb(164,158,158) |
rgb(53,58,76) |
grey |
navy |
multicolor |
| grey/melange |
rgb(128,129,125) |
rgb(66,62,63) |
grey |
dark |
multicolor |
| grey/khaki |
rgb(128,129,125) |
rgb(159,141,124) |
grey |
brown |
multicolor |
| charcoal/white |
rgb(104,103,103) |
rgb(254,254,254) |
dark |
white |
multicolor |
| toffe/black |
rgb(190,116,79) |
rgb(254,254,254) |
brown |
black |
multicolor |
| black/navy |
rgb(0,0,0) |
rgb(53,55,75) |
black |
navy |
multicolor |
| neon orange/white |
rgb(255,141,0) |
rgb(254,254,254) |
orange |
white |
multicolor |
| charcoal/black |
rgb(101,100,102) |
rgb(0,0,0) |
dark |
black |
multicolor |
| light rose/white |
rgb(240,197,196) |
rgb(254,254,254) |
pink |
white |
multicolor |
| amalfi teal |
rgb(53,78,82) |
|
bottle |
|
|
| pop tomato |
rgb(229,26,33) |
|
red |
|
|
| pop turquoise |
rgb(0,145,153) |
|
turquise |
|
|
| lotus blue |
rgb(163,199,233) |
|
sky |
|
|
| pop yellow |
rgb(251,185,0) |
|
yellow |
|
|
| acid lime |
rgb(197,212,46) |
|
lime |
|
|
| pop green |
rgb(0,166,109) |
|
green |
|
|
| heather blue |
rgb(140,156,181) |
|
sky |
|
|
| heather burgundy |
rgb(69,28,35) |
|
burgundy |
|
|
| heather grey fog |
rgb(211,206,192) |
|
cream |
|
|
| heather tarmac |
rgb(48,51,55) |
|
dark |
|
|
| lake blue |
rgb(50,133,197) |
|
blue |
|
|
| amalfi blue |
rgb(137,164,175) |
|
sky |
|
|
| mellow yellow |
rgb(250,191,23) |
|
yellow |
|
|
| tahiti coral |
rgb(244,155,83) |
|
orange |
|
|
| amalfi yellow |
rgb(245,235,180) |
|
yellow |
|
|
| amalfi coral |
rgb(240,129,93) |
|
orange |
|
|
| amalfi green |
rgb(119,153,126) |
|
green |
|
|
| amalfi grey |
rgb(167,162,151) |
|
grey |
|
|
| meta tuquoise |
rgb(107,196,201) |
|
turquise |
|
|
| navy pure |
rgb(32,34,50) |
|
navy |
|
|
| meta lilac |
rgb(88,58,116) |
|
purple |
|
|
| lotus pink |
rgb(237,106,158) |
|
pink |
|
|
| meta fuchsia |
rgb(198,38,85) |
|
pink |
|
|
| meta orange |
rgb(242,141,0) |
|
orange |
|
|
| blush pink |
rgb(243,207,199) |
|
pink |
|
|
| blush blue |
rgb(203,222,235) |
|
blue |
|
|
| blush mint |
rgb(211,229,214) |
|
sage |
|
|
| camo green |
rgb(95,95,79) |
|
army |
|
|
| ivy green |
rgb(21,80,52) |
|
bottle |
|
|
| dark forest |
rgb(6,43,34) |
|
bottle |
|
|
| roasted coffee |
rgb(68,51,46) |
|
brown |
|
|
| meta gold |
rgb(193,170,131) |
|
gold yellow |
|
| mastic |
rgb(196,177,148) |
|
cream |
|
|
| pixel coral |
rgb(235,93,63) |
|
orange |
|
|
| very turquoise |
rgb(67,192,232) |
|
turquise |
|
|
| pumpkin orange |
rgb(239,121,38) |
|
orange |
|
|
| real green |
rgb(58,170,53) |
|
green |
|
|
| chili gold |
rgb(251,186,0) |
|
gold yellow |
|
| denim blue |
rgb(27,54,93) |
|
denim |
|
|
| soft red |
rgb(216,70,82) |
|
red |
|
|
| seafoam |
rgb(97,187,170) |
|
turquise |
|
|
| citrus |
rgb(213,215,23) |
|
yellow |
|
|
| dark royal blue/navy |
rgb(1,45,91) |
rgb(0,21,44) |
blue |
navy |
multicolor |
| sporty grey/black |
rgb(48,61,77) |
rgb(0,0,0) |
dark |
black |
multicolor |
| black/sporty grey |
rgb(0,0,0) |
rgb(48,61,77) |
black |
dark |
multicolor |
| navy/oxford grey |
rgb(0,21,44) |
rgb(178,180,183) |
navy |
grey |
multicolor |
| whine/oxford grey |
rgb(254,254,254) |
rgb(178,180,183) |
white |
grey |
multicolor |
| oxford grey/white |
rgb(178,180,183) |
rgb(254,254,254) |
grey |
white |
multicolor |
| navy/red tartan |
rgb(0,21,44) |
rgb(224,74,90) |
navy |
red |
multicolor |
| navy/mariniere |
rgb(0,21,44) |
rgb(254,254,254) |
navy |
white |
multicolor |
| black/mexican skull |
rgb(0,0,0) |
rgb(120,120,120) |
black |
grey |
multicolor |
| black/skate graffiti |
rgb(0,0,0) |
rgb(204,144,131) |
black |
multicolor |
multicolor |
| sporty red/black |
rgb(219,14,21) |
rgb(0,0,0) |
red |
black |
multicolor |
| ocean blue heather |
rgb(37,92,148) |
rgb(37,77,119) |
blue |
|
|
| vintage navy |
rgb(40,44,69) |
|
navy |
|
|
| night blue heather |
rgb(118,130,140) |
rgb(94,103,110) |
blue |
|
|
| vintage dark red |
rgb(141,40,46) |
|
red |
|
|
| slub grey heather |
rgb(214,219,226) |
rgb(142,147,151) |
grey |
|
|
| vintage charcoal |
rgb(39,53,51) |
|
dark |
|
|
| navy/fine grey |
rgb(59,64,89) |
rgb(186,185,185) |
navy |
grey |
multicolor |
| light royal blue/yellow |
rgb(38,105,175) |
rgb(240,201,42) |
blue |
yellow |
multicolor |
| light royal blue/white |
rgb(38,105,175) |
rgb(254,254,254) |
blue |
white |
multicolor |
| tropical blue/white |
rgb(7,123,165) |
rgb(254,254,254) |
blue |
white |
multicolor |
| sky blue/white |
rgb(177,210,241) |
rgb(254,254,254) |
sky |
white |
multicolor |
| purple/oxford grey |
rgb(122,101,124) |
rgb(165,165,169) |
purple |
grey |
multicolor |
| fuchsia/ fine grey |
rgb(213,124,165) |
rgb(186,185,185) |
purple |
grey |
multicolor |
| light kelly green/white |
rgb(49,150,80) |
rgb(254,254,254) |
green |
white |
multicolor |
| black/fine grey |
rgb(0,0,1) |
rgb(185,185,185) |
black |
grey |
multicolor |
| white/fine grey |
rgb(254,254,254) |
|
white |
grey |
multicolor |
| cherry red |
rgb(166,38,48) |
|
red |
|
|
| emerald green |
rgb(31,92,95) |
|
bottle |
|
|
| orion blue |
rgb(55,75,89) |
|
blue |
|
|
| pumpkin |
rgb(209,117,41) |
|
orange |
|
|
| straw yellow |
rgb(253,241,168) |
|
yellow |
|
|
| caper green |
rgb(84,91,74) |
|
army |
|
|
| moka brown |
rgb(118,101,92) |
|
brown |
|
|
| olive camouflage |
rgb(153,134,109) |
rgb(96,105,91) |
army |
|
|
| grey camouflage |
rgb(172,172,172) |
rgb(100,100,100) |
grey |
|
|
| Sweet grey |
rgb(171,172,169) |
|
grey |
|
|
| oxford grey/black |
rgb(175,173,177) |
rgb(0,0,0) |
grey |
black |
multicolor |
| black/oxford grey |
rgb(0,0,0) |
rgb(175,173,177) |
black |
grey |
multicolor |
| navy/royal blue |
rgb(0,21,44) |
rgb(0,75,147) |
navy |
blue |
multicolor |
| bordeaux/white |
rgb(121,33,28) |
rgb(254,254,254) |
burgundy |
white |
multicolor |
| black/green |
rgb(0,0,0) |
rgb(77,163,47) |
black |
green |
multicolor |
| light turquoise/white |
rgb(0,181,216) |
rgb(254,254,254) |
turquise |
white |
multicolor |
| deep navy |
rgb(18,18,39) |
|
navy |
|
|
| true coral |
rgb(226,97,98) |
|
orange |
|
|
| fluorescent pink |
rgb(234,79,134) |
|
pink |
|
|
| duck blue heather |
rgb(62,100,123) |
rgb(50,77,94) |
turquise |
|
|
| light grey heather |
rgb(194,202,209) |
rgb(224,230,236) |
grey |
|
|
| sporty royal blue |
rgb(47,82,145) |
|
blue |
|
|
| aqua blue |
rgb(25,120,189) |
|
blue |
|
|
| true yellow |
rgb(243,207,41) |
|
yellow |
|
|
| fluorescent orange |
rgb(213,122,41) |
|
orange |
|
|
| oxford grey/navy |
rgb(179,181,184) |
rgb(55,55,82) |
grey |
navy |
multicolor |
| navy/sky |
rgb(55,55,82) |
rgb(197,221,244) |
navy |
sky |
multicolor |
| black/yellow |
rgb(0,0,0) |
rgb(255,236,27) |
black |
yellow |
multicolor |
| navy/orange |
rgb(64,64,92) |
rgb(213,122,41) |
navy |
orange |
multicolor |
| royal blue/yellow |
rgb(47,82,145) |
rgb(255,236,27) |
blue |
yellow |
multicolor |
| ice/denim |
rgb(209,19,96) |
rgb(44,67,115) |
blue |
denim |
multicolor |
| red/yellow |
rgb(195,36,42) |
rgb(255,236,27) |
red |
yellow |
multicolor |
| orange/light grey |
rgb(213,122,41) |
rgb(193,193,193) |
orange |
grey |
multicolor |
| light grey/red |
rgb(193,193,193) |
rgb(195,36,42) |
grey |
red |
multicolor |
| slate grey/black |
rgb(95,94,94) |
rgb(0,0,0) |
grey |
black |
multicolor |
| white/forest green |
rgb(254,254,254) |
rgb(43,89,68) |
white |
bottle |
multicolor |
| deep purple |
rgb(64,72,95) |
|
purple |
|
|
| french navy heather |
rgb(35,49,68) |
|
navy |
|
|
| true indigo |
rgb(55,77,88) |
|
blue |
|
|
| snow grey |
rgb(171,175,176) |
|
grey |
|
|
| light orange |
rgb(221,149,75) |
|
orange |
|
|
| lemon yellow |
rgb(227,224,138) |
|
lime |
|
|
| sea turquoise |
rgb(67,167,189) |
|
turquise |
|
|
| wine heather |
rgb(73,36,41) |
|
burgundy |
|
|
| cloudy blue heather |
rgb(99,153,175) |
|
sky |
|
|
| deep blue |
rgb(63,57,96) |
|
blue |
|
|
| terracota red |
rgb(156,45,51) |
|
burgundy |
|
|
| light orange |
rgb(214,126,72) |
|
orange |
|
|
| green marble heather |
rgb(108,109,104) |
|
army |
|
|
| heather/dark grey |
rgb(190,191,193) |
rgb(36,54,69) |
cream |
grey |
multicolor |
| heather |
rgb(190,191,193) |
|
cream |
|
|
| bright pink/carbon |
rgb(204,82,117) |
rgb(107,107,106) |
pink |
dark |
multicolor |
| black/silver |
rgb(0,0,0) |
rgb(180,180,180) |
black |
grey |
multicolor |
| jungle green/black |
rgb(99,105,42) |
rgb(1,1,1) |
green |
black |
multicolor |
| navy/silver |
rgb(37,54,80) |
rgb(188,195,199) |
navy |
grey |
multicolor |
| plum/glacier grey |
rgb(76,34,52) |
rgb(92,97,105) |
purple |
grey |
multicolor |
| coal black/grey |
rgb(34,37,36) |
rgb(163,164,169) |
black |
grey |
multicolor |
| glacier grey/carbon |
rgb(92,97,105) |
rgb(107,107,106) |
grey |
dark |
multicolor |
| light red |
rgb(195,36,42) |
|
red |
|
|
| caramel/black |
rgb(204,174,117) |
rgb(0,1,0) |
brown |
black |
multicolor |
| ink/black |
rgb(43,69,117) |
rgb(0,1,0) |
blue |
black |
multicolor |
| coffe/black |
rgb(100,77,37) |
rgb(0,1,0) |
brown |
black |
multicolor |
| black/off white |
rgb(0,1,0) |
rgb(249,246,242) |
black |
white |
multicolor |
| royal melange/navy |
rgb(44,61,104) |
rgb(37,54,80) |
blue |
navy |
multicolor |
| red melange/black |
rgb(178,44,50) |
rgb(0,1,0) |
red |
black |
multicolor |
| dark green melange/black |
rgb(98,112,88) |
rgb(0,1,0) |
bottle |
black |
multicolor |
| stone melange/black |
rgb(207,197,177) |
rgb(0,1,0) |
cream |
black |
multicolor |
| carbon melange/black |
rgb(93,95,99) |
rgb(0,1,0) |
dark |
black |
multicolor |
| white melange/carbon |
rgb(210,211,214) |
rgb(107,107,106) |
white |
dark |
multicolor |
| turquoise melange/dark grey |
rgb(19,161,213) |
rgb(102,102,101) |
turquise |
dark |
multicolor |
| wine melange/dark grey |
rgb(135,40,44) |
rgb(102,102,101) |
red |
dark |
multicolor |
| yellow melange/dark grey |
rgb(244,211,35) |
rgb(102,102,101) |
yellow |
dark |
multicolor |
| green melange/dark grey |
rgb(123,168,154) |
rgb(102,102,101) |
green |
dark |
multicolor |
| grey heather/dark grey |
rgb(173,172,172) |
rgb(102,102,101) |
grey |
dark |
multicolor |
| black melange/dark grey |
rgb(10,12,15) |
rgb(102,102,101) |
black |
dark |
multicolor |
| purple/lime green |
rgb(139,81,149) |
rgb(200,209,115) |
purple |
lime |
multicolor |
| aqua/lime green |
rgb(74,120,186) |
rgb(200,209,115) |
blue |
lime |
multicolor |
| neon orange/neon green |
rgb(225,159,62) |
rgb(199,209,53) |
orange |
lime |
multicolor |
| royal/carbon |
rgb(56,68,128) |
rgb(107,107,106) |
blue |
dark |
multicolor |
| bright orange/carbon |
rgb(215,132,104) |
rgb(107,107,106) |
orange |
dark |
multicolor |
| bright yellow/carbon |
rgb(209,214,49) |
rgb(107,107,106) |
yellow |
dark |
multicolor |
| grey melange/carbon |
rgb(110,100,110) |
rgb(107,107,106) |
grey |
dark |
multicolor |
| turquoise/lime green |
rgb(24,161,202) |
rgb(200,209,115) |
turquise |
lime |
multicolor |
| royal/red |
rgb(56,68,128) |
rgb(196,41,41) |
blue |
red |
multicolor |
| yellow/light grey |
rgb(255,236,27) |
rgb(211,206,191) |
yellow |
grey |
multicolor |
| lime green/royal |
rgb(200,209,115) |
rgb(56,68,128) |
lime |
blue |
multicolor |
| light grey/dark grey |
rgb(211,206,191) |
rgb(102,102,101) |
grey |
dark |
multicolor |
| light grey/burgundy |
rgb(211,206,191) |
rgb(181,38,101) |
grey |
burgundy |
multicolor |
| grey melange/light grey melange |
rgb(110,100,110) |
rgb(162,162,162) |
dark |
grey |
multicolor |
| white/lime green |
rgb(254,254,254) |
rgb(200,209,115) |
white |
lime |
multicolor |
| navy/carbon |
rgb(37,54,80) |
rgb(107,107,106) |
navy |
dark |
multicolor |
| bright blue/carbon |
rgb(62,153,76) |
rgb(107,107,106) |
blue |
dark |
multicolor |
| fern green/carbon |
rgb(62,153,76) |
rgb(107,107,106) |
green |
dark |
multicolor |
| heather grey/carbon |
rgb(173,172,172) |
rgb(107,107,106) |
grey |
dark |
multicolor |
| green/acid yellow |
rgb(45,143,89) |
rgb(201,210,52) |
green |
lime |
multicolor |
| carbon/yellow |
rgb(104,102,112) |
rgb(255,236,27) |
dark |
yellow |
multicolor |
| red/dark grey |
rgb(196,41,41) |
rgb(102,102,101) |
red |
dark |
multicolor |
| fuchsia/lime green |
rgb(203,80,135) |
rgb(198,216,154) |
pink |
lime |
multicolor |
| sand/brown |
rgb(239,220,172) |
rgb(95,72,49) |
cream |
brown |
multicolor |
| brown/turquoise |
rgb(95,72,49) |
rgb(24,161,202) |
brown |
turquise |
multicolor |
| light grey/yellow |
rgb(228,228,229) |
rgb(240,200,61) |
grey |
yellow |
multicolor |
| grey/green |
rgb(163,164,169) |
rgb(50,150,77) |
grey |
green |
multicolor |
| blue melange |
rgb(101,147,205) |
rgb(106,139,167) |
blue |
grey |
multicolor |
| orange/aqua |
rgb(220,147,72) |
rgb(24,121,189) |
orange |
blue |
multicolor |
| carbon/red |
rgb(132,9,45) |
rgb(196,38,60) |
dark |
red |
multicolor |
| black/pink |
rgb(0,0,0) |
rgb(196,30,85) |
black |
pink |
multicolor |
| black/turquoise |
rgb(0,0,0) |
rgb(24,161,202) |
black |
turquise |
multicolor |
| bright blue |
rgb(26,125,193) |
|
blue |
|
|
| titan |
rgb(86,84,90) |
|
dark |
|
|
| dark green/beige |
rgb(37,91,73) |
rgb(226,216,204) |
bottle |
cream |
multicolor |
| light grey/light pink |
rgb(228,228,229) |
rgb(200,63,99) |
grey |
pink |
multicolor |
| black/mint |
rgb(0,0,0) |
rgb(138,194,203) |
black |
sage |
multicolor |
| Fluorescent yellow |
rgb(249,233,31) |
|
yellow |
|
|
| girl pink |
rgb(200,63,99) |
|
pink |
|
|
| smaragd |
rgb(18,119,138) |
|
turquise |
|
|
| dark navy |
rgb(37,42,57) |
|
navy |
|
|
| bright pink |
rgb(208,87,107) |
|
pink |
|
|
| bright orange |
rgb(215,132,104) |
|
orange |
|
|
| denim melange |
rgb(79,87,116) |
rgb(100,109,139) |
denim |
|
|
| bright yellow |
rgb(247,217,38) |
|
yellow |
|
|
| heather/navy |
rgb(190,190,193) |
rgb(45,50,91) |
cream |
navy |
multicolor |
| heather/black |
rgb(190,190,193) |
rgb(0,0,0) |
cream |
black |
multicolor |
| olive melange |
rgb(94,92,76) |
rgb(108,106,90) |
army |
|
|
| black melange |
rgb(19,17,8) |
rgb(39,47,38) |
black |
|
|
| clay |
rgb(119,106,95) |
|
cream |
|
|
| royal/tomato |
rgb(57,68,128) |
rgb(221,5,43) |
blue |
red |
multicolor |
| black/pacific |
rgb(0,0,0) |
rgb(0,146,212) |
black |
blue |
multicolor |
| pink/black |
rgb(233,66,113) |
rgb(0,0,0) |
pink |
black |
multicolor |
| black/sun yellow |
rgb(0,0,0) |
rgb(250,233,28) |
black |
yellow |
multicolor |
| black/tomato |
rgb(0,0,0) |
rgb(221,5,43) |
black |
red |
multicolor |
| black/fern green |
rgb(0,0,0) |
rgb(0,176,62) |
black |
green |
multicolor |
| neon orange/neon yellow |
rgb(231,130,16) |
rgb(253,235,63) |
orange |
yellow |
multicolor |
| neon yellow/neon orange |
rgb(253,235,63) |
rgb(231,130,16) |
lime |
orange |
multicolor |
| white/carbon |
rgb(254,254,254) |
rgb(161,165,167) |
white |
dark |
multicolor |
| chrome |
rgb(221,227,230) |
|
sky |
|
|
| gold yellow/white |
rgb(252,191,32) |
rgb(254,254,254) |
gold yellow |
white |
multicolor |
| iron grey |
rgb(95,94,94) |
|
dark |
|
|
| royal/navy |
rgb(0,72,132) |
rgb(204,100,33) |
blue |
navy |
multicolor |
| navy/light grey |
rgb(0,50,84) |
rgb(227,227,227) |
navy |
grey |
multicolor |
| aqua/white |
rgb(86,146,206) |
rgb(254,254,254) |
blue |
white |
multicolor |
| dark green/black |
rgb(0,85,67) |
rgb(0,0,0) |
bottle |
black |
multicolor |
| dark green/red |
rgb(0,85,67) |
rgb(201,25,34) |
bottle |
red |
multicolor |
| black/dark green |
rgb(0,0,0) |
rgb(0,85,67) |
black |
bottle |
multicolor |
| navy/light blue |
rgb(204,100,33) |
rgb(202,12,99) |
navy |
sky |
multicolor |
| dark green/natural |
rgb(0,86,67) |
rgb(207,203,187) |
bottle |
cream |
multicolor |
| light khaki |
rgb(194,174,151) |
|
brown |
|
|
| white/gold yellow |
rgb(254,254,254) |
rgb(250,192,20) |
white |
gold yellow |
multicolor |
| black/gold yellow |
rgb(0,0,0) |
rgb(250,192,20) |
black |
gold yellow |
multicolor |
| brown/grey melange |
rgb(120,113,92) |
rgb(112,111,122) |
brown |
dark |
multicolor |
| white/grey melange |
rgb(254,254,254) |
rgb(112,111,122) |
white |
dark |
multicolor |
| carbon/light grey |
rgb(107,107,106) |
rgb(225,220,215) |
dark |
grey |
multicolor |
| anthracite |
rgb(66,66,65) |
|
dark |
|
|
| bordeaux |
rgb(175,44,33) |
|
burgundy |
|
|
| gold yellow/royal |
rgb(252,191,32) |
rgb(57,68,128) |
gold yellow |
blue |
multicolor |
| turquoise/beige |
rgb(0,161,212) |
rgb(224,214,202) |
turquise |
cream |
multicolor |
| lime green/beige |
rgb(181,214,32) |
rgb(224,214,202) |
lime |
cream |
multicolor |
| green/beige |
rgb(0,159,72) |
rgb(224,214,202) |
green |
cream |
multicolor |
| beige/black |
rgb(224,214,202) |
rgb(0,0,0) |
cream |
black |
multicolor |
| black/neon green |
rgb(0,0,0) |
rgb(48,255,25) |
black |
lime |
multicolor |
| blacck/gold yellow |
rgb(0,0,0) |
rgb(252,191,32) |
black |
gold yellow |
multicolor |
| natural/light grey |
rgb(255,239,195) |
rgb(178,178,178) |
cream |
grey |
multicolor |
| signal red |
rgb(230,54,18) |
|
red |
|
|
| light khaki/navy |
rgb(164,174,151) |
rgb(0,50,84) |
brown |
navy |
multicolor |
| light khaki/black |
rgb(164,174,151) |
rgb(0,0,0) |
brown |
black |
multicolor |
| beige/dark green |
rgb(224,214,202) |
rgb(36,83,41) |
cream |
bottle |
multicolor |
| black/charcoal |
rgb(0,0,0) |
rgb(84,70,84) |
cream |
dark |
multicolor |
| light grey/navy |
rgb(225,220,215) |
rgb(0,46,81) |
grey |
navy |
multicolor |
| magenta/magenta |
rgb(216,0,91) |
rgb(232,51,126) |
pink |
|
|
| green/green |
rgb(75,146,40) |
rgb(56,147,10) |
green |
|
|
| neon pink/white |
rgb(255,0,217) |
rgb(254,254,254) |
pink |
white |
multicolor |
| sun yellow/black |
rgb(255,250,3) |
rgb(0,0,0) |
yellow |
black |
multicolor |
| black/neon yellow |
rgb(0,0,0) |
rgb(255,251,0) |
black |
yellow |
multicolor |
| white/pacific |
rgb(254,254,254) |
rgb(116,201,229) |
white |
blue |
multicolor |
| white/light blue |
rgb(254,254,254) |
rgb(223,242,253) |
white |
sky |
multicolor |
| white/lilac |
rgb(254,254,254) |
rgb(204,198,228) |
white |
purple |
multicolor |
| white/baby pink |
rgb(254,254,254) |
rgb(252,141,202) |
white |
pink |
multicolor |
| white/neon pink |
rgb(254,254,254) |
rgb(255,3,142) |
white |
pink |
multicolor |
| white/magenta |
rgb(254,254,254) |
rgb(216,0,91) |
white |
pink |
multicolor |
| white/neon green |
rgb(254,254,254) |
rgb(65,240,45) |
white |
lime |
multicolor |
| white/dark green |
rgb(254,254,254) |
rgb(0,86,67) |
white |
bottle |
multicolor |
| white/light grey |
rgb(254,254,254) |
rgb(225,220,215) |
white |
grey |
multicolor |
| white/graphite |
rgb(254,254,254) |
rgb(76,86,92) |
white |
dark |
multicolor |
| navy/beige |
rgb(0,50,84) |
rgb(224,214,202) |
navy |
cream |
multicolor |
| pacific/white |
rgb(116,201,229) |
rgb(254,254,254) |
blue |
white |
multicolor |
| light pink/white |
rgb(253,236,240) |
rgb(254,254,254) |
pink |
white |
multicolor |
| gold yellow/navy |
rgb(252,191,32) |
rgb(0,50,84) |
gold yellow |
navy |
multicolor |
| sun yellow/white |
rgb(250,233,28) |
rgb(254,254,254) |
yellow |
white |
multicolor |
| lime green/white |
rgb(214,227,98) |
rgb(254,254,254) |
lime |
white |
multicolor |
| fern green/white |
rgb(0,176,62) |
rgb(254,254,254) |
green |
white |
multicolor |
| olive/beige |
rgb(89,85,60) |
rgb(224,214,202) |
army |
cream |
multicolor |
| beige/navy |
rgb(224,214,202) |
rgb(0,50,84) |
cream |
navy |
multicolor |
| graphite/light grey |
rgb(76,86,92) |
rgb(227,227,227) |
dark |
grey |
multicolor |
| black/light grey |
rgb(0,0,0) |
rgb(227,227,227) |
black |
grey |
multicolor |
| black/beige |
rgb(0,0,0) |
rgb(224,214,202) |
black |
cream |
multicolor |
| carbon |
rgb(102,112,125) |
|
dark |
|
|
| wine |
rgb(140,48,66) |
|
burgundy |
|
|
| atlantic |
rgb(0,115,171) |
|
blue |
|
|
| mauve |
rgb(77,48,105) |
|
purple |
|
|
| sunny lime |
rgb(195,167,53) |
|
lime |
|
|
| dark brown |
rgb(75,57,31) |
|
brown |
|
|
| natural/true pink |
rgb(255,239,195) |
rgb(236,127,168) |
cream |
pink |
multicolor |
| soft white/rose gold |
rgb(241,240,236) |
rgb(231,178,164) |
white |
cream |
multicolor |
| soft white/light grey |
rgb(241,240,236) |
rgb(178,178,178) |
white |
grey |
multicolor |
| soft white/black |
rgb(241,240,236) |
rgb(0,0,0) |
white |
black |
multicolor |
| black/natura |
rgb(0,0,0) |
rgb(255,239,195) |
black |
cream |
multicolor |
| khaki camouflage |
rgb(215,189,169) |
rgb(116,105,94) |
army |
|
|
| white camouflage |
rgb(245,245,245) |
rgb(126,135,100) |
white |
|
|
| stone/brown |
rgb(220,217,207) |
rgb(25,87,73) |
cream |
brown |
multicolor |
| natural/bright red |
rgb(250,236,193) |
rgb(196,40,58) |
cream |
red |
multicolor |
| natural/surf blue |
rgb(250,236,193) |
rgb(42,164,205) |
cream |
blue |
multicolor |
| natural/orange rust |
rgb(250,236,193) |
rgb(188,78,41) |
cream |
orange |
multicolor |
| red stripe |
rgb(244,242,230) |
rgb(217,190,191) |
cream |
red |
multicolor |
| grey stripe |
rgb(244,242,230) |
rgb(202,202,203) |
cream |
grey |
multicolor |
| duck egg blue |
rgb(171,189,192) |
|
turquise |
|
|
| blosson |
rgb(227,188,185) |
|
pink |
|
|
| safron |
rgb(224,189,93) |
|
gold yellow |
|
| natural/olive green |
rgb(250,236,193) |
rgb(83,86,72) |
cream |
army |
multicolor |
| natural/amber |
rgb(250,236,193) |
rgb(220,80,43) |
cream |
gold yellow |
multicolor |
| natural/sage green |
rgb(250,236,193) |
rgb(101,139,136) |
cream |
sage |
multicolor |
| indigo blue |
rgb(85,112,138) |
|
blue |
|
|
| pomegranate rose |
rgb(224,162,152) |
|
orange |
|
|
| sea salt |
rgb(247,245,242) |
|
cream |
|
|
| myrobalan stone |
rgb(193,177,160) |
|
cream |
|
|
| natural/forest green |
rgb(250,236,193) |
rgb(165,195,91) |
cream |
bottle |
multicolor |
| graphite grey/graphite grey |
rgb(120,2,32) |
rgb(120,20,32) |
dark |
grey |
multicolor |
| natural/pink |
rgb(250,236,193) |
rgb(228,178,195) |
cream |
pink |
multicolor |
| natural/grey |
rgb(250,236,193) |
rgb(178,178,178) |
cream |
grey |
multicolor |
| pastel mint/white |
rgb(220,231,223) |
rgb(254,254,254) |
sage |
white |
multicolor |
| pastel blue/white |
rgb(223,228,237) |
rgb(254,254,254) |
sky |
white |
multicolor |
| levender/white |
rgb(188,155,197) |
rgb(254,254,254) |
purple |
white |
multicolor |
| classic pink/white |
rgb(233,160,199) |
rgb(254,254,254) |
pink |
white |
multicolor |
| pastel pink/white |
rgb(236,220,218) |
rgb(254,254,254) |
pink |
white |
multicolor |
| petrol |
rgb(33,76,103) |
|
sage |
|
|
| burgundy/white |
rgb(123,39,50) |
rgb(254,254,254) |
burgundy |
white |
multicolor |
| navy/khaki |
rgb(35,43,75) |
rgb(214,195,151) |
navy |
brown |
multicolor |
| light blue/navy |
rgb(108,181,210) |
rgb(35,43,75) |
sky |
navy |
multicolor |
| orange/grey |
rgb(227,70,20) |
rgb(198,195,195) |
orange |
grey |
multicolor |
| grey/grey |
rgb(198,197,199) |
rgb(198,195,195) |
grey |
|
|
| coconut milk |
rgb(218,217,215) |
|
white |
|
|
| avio |
rgb(44,85,116) |
|
blue |
|
|
| navy/dark grey |
rgb(70,68,67) |
|
navy |
dark |
multicolor |
| orange/white |
rgb(219,127,86) |
rgb(254,254,254) |
orange |
white |
multicolor |
| yellow/white |
rgb(221,141,20) |
rgb(254,254,254) |
yellow |
white |
multicolor |
| ecru/navy |
rgb(206,207,183) |
rgb(35,43,75) |
cream |
navy |
multicolor |
| khaki/burgundy |
rgb(214,195,151) |
rgb(123,39,50) |
brown |
burgundy |
multicolor |
| navy/black |
rgb(35,43,75) |
rgb(0,0,0) |
navy |
black |
multicolor |
| burgundy/black |
rgb(123,39,50) |
rgb(0,0,0) |
burgundy |
black |
multicolor |
| light grey/black |
rgb(198,197,199) |
rgb(0,0,0) |
grey |
black |
multicolor |
| navy/burgundy |
rgb(35,43,75) |
rgb(123,39,50) |
navy |
burgundy |
multicolor |
| royal/grey |
rgb(39,55,114) |
rgb(198,197,199) |
blue |
grey |
multicolor |
| white/burgundy |
rgb(254,254,254) |
rgb(123,39,50) |
white |
burgundy |
multicolor |
| olive/khaki |
rgb(94,101,54) |
rgb(214,195,151) |
army |
brown |
multicolor |
| dark grey/red |
rgb(67,72,74) |
rgb(202,37,41) |
dark |
red |
multicolor |
| grey/bright yellow |
rgb(198,197,199) |
rgb(255,233,35) |
grey |
yellow |
multicolor |
| grey/black |
rgb(198,197,199) |
rgb(0,0,0) |
grey |
black |
multicolor |
| grey/burgundy |
rgb(198,197,199) |
rgb(123,39,50) |
grey |
burgundy |
multicolor |
| white/yellow |
rgb(254,254,254) |
rgb(255,215,6) |
white |
yellow |
multicolor |
| columbia blue |
rgb(91,138,181) |
|
sky |
|
|
| cardinal red |
rgb(159,41,67) |
|
burgundy |
|
|
| navy/yellow |
rgb(35,43,75) |
rgb(50,98,100) |
navy |
yellow |
multicolor |
| light green |
rgb(0,132,64) |
|
green |
|
|
| avio melange |
rgb(56,62,114) |
|
turquise |
|
|
| royal melange |
rgb(53,68,150) |
|
blue |
|
|
| purple melange |
rgb(154,116,154) |
|
purple |
|
|
| red melange |
rgb(218,48,108) |
|
red |
|
|
| č |
rgb(81,80,79) |
|
dark |
|
|
| light pink |
rgb(248,201,219) |
|
pink |
|
|
| royal/black |
rgb(39,55,114) |
rgb(0,0,0) |
blue |
black |
multicolor |
| khaki/black |
rgb(203,204,161) |
rgb(0,0,0) |
brown |
black |
multicolor |
| black/dark grey |
rgb(0,0,0) |
rgb(67,72,74) |
black |
dark |
multicolor |
| bottle green/grey |
rgb(8,48,37) |
rgb(198,197,199) |
bottle |
grey |
multicolor |
| grey melange/cardinal |
rgb(186,177,174) |
rgb(159,41,67) |
dark |
burgundy |
multicolor |
| bottle green/white |
rgb(8,48,37) |
rgb(254,254,254) |
bottle |
white |
multicolor |
| burgundy/navy |
rgb(723,39,50) |
rgb(35,43,75) |
burgundy |
navy |
multicolor |
| orange/navy |
rgb(202,82,41) |
rgb(35,43,75) |
orange |
navy |
multicolor |
| royal |
rgb(39,55,114) |
|
blue |
|
|
| light blue/white |
rgb(108,181,210) |
rgb(254,254,254) |
sky |
white |
multicolor |
| burgundy/natural |
rgb(123,39,50) |
rgb(239,221,187) |
burgundy |
cream |
multicolor |
| red/navy |
rgb(202,37,41) |
rgb(35,43,75) |
red |
navy |
multicolor |
| yellow/navy |
rgb(255,215,6) |
rgb(35,43,75) |
yellow |
navy |
multicolor |
| light green/white |
rgb(0,132,64) |
rgb(254,254,254) |
green |
white |
multicolor |
| olive/natural |
rgb(94,101,54) |
rgb(239,221,187) |
army |
cream |
multicolor |
| green/white |
rgb(94,101,54) |
rgb(254,254,254) |
green |
white |
multicolor |
| brown/natural |
rgb(107,87,73) |
rgb(239,221,187) |
brown |
cream |
multicolor |
| khaki/navy |
rgb(214,195,151) |
rgb(35,43,75) |
brown |
navy |
multicolor |
| natural/navy |
rgb(239,221,187) |
rgb(35,43,75) |
cream |
navy |
multicolor |
| grey/navy |
rgb(198,197,199) |
rgb(35,43,75) |
grey |
navy |
multicolor |
| light grey/white |
rgb(198,197,199) |
rgb(254,254,254) |
grey |
white |
multicolor |
| black grey/black |
rgb(124,111,106) |
rgb(0,0,0) |
dark |
black |
multicolor |
| navy/cardinal |
rgb(35,43,75) |
rgb(159,41,67) |
navy |
burgundy |
multicolor |
| navy/grey melange |
rgb(35,43,75) |
rgb(186,177,174) |
navy |
dark |
multicolor |
| cardinal/black |
rgb(159,41,67) |
rgb(0,0,0) |
burgundy |
black |
multicolor |
| grey melange/black |
rgb(186,177,174) |
rgb(0,0,0) |
dark |
black |
multicolor |
| black/grey melange |
rgb(0,0,0) |
rgb(186,177,174) |
black |
dark |
multicolor |
| olive/white |
rgb(94,101,54) |
rgb(254,254,254) |
army |
white |
multicolor |
| khaki/khaki |
rgb(214,195,151) |
rgb(210,190,148) |
brown |
|
|
| navy/white |
rgb(35,45,75) |
rgb(254,254,254) |
navy |
white |
multicolor |
| grey/white |
rgb(198,197,199) |
rgb(254,254,254) |
grey |
white |
multicolor |
| dark grey/white |
rgb(67,72,74) |
rgb(254,254,254) |
dark |
white |
multicolor |
| columbia blue/navy |
rgb(91,138,181) |
rgb(35,43,75) |
sky |
navy |
multicolor |
| red/navy |
rgb(196,41,42) |
rgb(35,43,75) |
red |
navy |
multicolor |
| sage |
rgb(133,152,149) |
|
sage |
|
|
| dark mustard |
rgb(143,90,39) |
|
gold yellow |
|
| heather blue |
rgb(131,160,200) |
|
sky |
|
|
| heather pink |
rgb(218,190,212) |
|
pink |
|
|
| gold/black |
rgb(236,190,44) |
rgb(0,0,0) |
gold yellow |
black |
multicolor |
| army/black |
rgb(88,79,60) |
rgb(0,0,0) |
army |
black |
multicolor |
| graphite/black |
rgb(111,117,116) |
rgb(0,0,0) |
dark |
black |
multicolor |
| black/apple green |
rgb(0,0,0) |
rgb(191,208,100) |
black |
green |
multicolor |
| royal blue/black |
rgb(47,85,150) |
rgb(0,0,0) |
blue |
black |
multicolor |
| red/black |
rgb(195,35,41) |
rgb(0,0,0) |
red |
black |
multicolor |
| camouflage |
rgb(145,128,113) |
rgb(110,108,72) |
army |
|
|
| graphite |
rgb(111,117,116) |
|
dark |
|
|
| dune |
rgb(199,182,134) |
|
cream |
|
|
| army/shear beige |
rgb(88,79,60) |
rgb(206,199,190) |
army |
cream |
multicolor |
| carbon grey/shear beige |
rgb(56,55,59) |
rgb(206,199,190) |
dark |
cream |
multicolor |
| royal/white |
rgb(47,85,150) |
rgb(254,254,254) |
blue |
white |
multicolor |
| beige/white |
rgb(231,219,175) |
rgb(254,254,254) |
cream |
white |
multicolor |
| royal blue/white |
rgb(47,85,150) |
rgb(254,254,254) |
blue |
white |
multicolor |
| black/royal blue |
rgb(35,33,37) |
rgb(47,85,150) |
black |
blue |
multicolor |
| army/beige |
rgb(88,79,60) |
rgb(230,218,174) |
army |
cream |
multicolor |
| turquise/white |
rgb(0,180,213) |
rgb(245,245,245) |
turquise |
white |
multicolor |
| pink/white, |
rgb(245,178,202) |
rgb(245,245,245) |
pink |
white |
multicolor |
| kelly green/white |
rgb(0,142,77) |
rgb(245,245,245) |
green |
white |
multicolor |
| chocolate/beige |
rgb(58,40,32) |
rgb(230,218,174) |
brown |
cream |
multicolor |
| dark grey/light grey |
rgb(107,107,106) |
rgb(195,191,184) |
dark |
grey |
multicolor |
| black/royal |
rgb(1,1,1) |
rgb(0,78,151) |
black |
blue |
multicolor |
| white/french navy |
rgb(245,245,245) |
rgb(20,44,68) |
white |
navy |
multicolor |
| chilli |
rgb(111,32,31) |
|
burgundy |
|
|
| bud green |
rgb(69,138,66) |
|
green |
|
|
| french navy/red |
rgb(20,44,68) |
rgb(203,22,39) |
navy |
red |
multicolor |
| grey melange/burgundy |
rgb(117,113,121) |
rgb(79,30,48) |
dark |
burgundy |
multicolor |
| charcoal melange/black |
rgb(8,14,16) |
rgb(1,1,1) |
dark |
black |
multicolor |
| deep grey melange |
rgb(109,109,114) |
|
grey |
|
|
| flanel grey |
rgb(81,85,85) |
|
dark |
|
|
| deep charcoal |
rgb(10,10,10) |
|
dark |
|
|
| french navy/neon orange |
rgb(35,49,68) |
rgb(218,141,41) |
navy |
orange |
multicolor |
| red/white |
rgb(195,35,41) |
rgb(254,254,254) |
red |
white |
multicolor |
| lime/white |
rgb(83,29,82) |
rgb(254,254,254) |
lime |
white |
multicolor |
| forest green/white |
rgb(37,82,62) |
rgb(254,254,254) |
bottle |
white |
multicolor |
| grey melange/french navy |
rgb(117,113,121) |
rgb(35,49,68) |
dark |
navy |
multicolor |
| grey melange/orange |
rgb(117,113,121) |
rgb(205,92,41) |
dark |
orange |
multicolor |
| black/lime |
rgb(0,1,0) |
rgb(83,29,82) |
black |
lime |
multicolor |
| black/white |
rgb(0,1,0) |
rgb(254,254,254) |
black |
white |
multicolor |
| white/aqua |
rgb(254,254,254) |
rgb(17,159,204) |
white |
blue |
multicolor |
| slate blue |
rgb(22,95,124) |
, |
blue |
|
|
| golf green |
rgb(39,82,50) |
|
bottle |
|
|
| carbon grey |
rgb(56,55,59) |
|
dark |
|
|
| baby blue |
rgb(201,219,227) |
|
sky |
|
|
| dark pink |
rgb(196,38,65) |
|
pink |
|
|
| french navy/white |
rgb(20,44,68) |
rgb(243,243,243) |
navy |
white |
multicolor |
| recycled navy |
rgb(35,41,53) |
|
navy |
|
|
| recycled black |
rgb(2,2,2) |
|
black |
|
|
| recycled white |
rgb(240,240,240) |
|
white |
|
|
| blue camo |
rgb(115,140,171) |
rgb(66,91,138) |
blue |
|
|
| camo |
rgb(154,135,120) |
rgb(114,110,73) |
army |
|
|
| grey camo |
rgb(199,196,191) |
rgb(91,86,82) |
grey |
|
|
| bright green |
rgb(0,160,58) |
|
lime |
|
|
| green empire |
rgb(38,74,72) |
|
bottle |
|
|
| arctic blue |
rgb(182,228,226) |
|
sky |
|
|
| black/red |
rgb(0,0,0) |
rgb(203,22,39) |
black |
red |
multicolor |
| black/grey melange |
rgb(0,0,0) |
rgb(123,127,130) |
black |
dark |
multicolor |
| white/navy |
rgb(255,255,255) |
rgb(3,44,82) |
white |
navy |
multicolor |
| white/royal |
rgb(255,255,255) |
rgb(0,78,151) |
white |
blue |
multicolor |
| white/red |
rgb(255,255,255) |
rgb(203,22,39) |
white |
red |
multicolor |
| white/orange |
rgb(255,255,255) |
rgb(237,94,39) |
white |
orange |
multicolor |
| white/black |
rgb(255,255,255) |
rgb(0,0,0) |
white |
black |
multicolor |
| heather denim |
rgb(83,90,109) |
|
denim |
|
|
| heather oxblood |
rgb(72,36,37) |
|
burgundy |
|
|
| heather khaki |
rgb(111,104,74) |
|
army |
|
|
| pool blue |
rgb(104,156,184) |
|
turquise |
|
|
| oxblood |
rgb(79,28,39) |
|
burgundy |
|
|
| petroleum blue |
rgb(0,43,60) |
|
navy |
|
|
| neon pink |
rgb(232,57,121) |
|
pink |
|
|
| light grey melange |
rgb(176,178,189) |
|
grey |
|
|
| absolute white |
rgb(255,254,255) |
|
white |
|
|
| orange |
rgb(250,117,0) |
|
orange |
|
|
| red |
rgb(222,17,16) |
|
red |
|
|
| aquamarín |
rgb(20,209,203) |
|
turquise |
|
|
| tmavá růžová |
rgb(201,0,201) |
|
pink |
|
|
| astral purple |
rgb(115,47,66) |
|
burgundy |
|
|
| pop orange |
rgb(230,118,82) |
|
orange |
|
|
| fialová |
rgb(174,6,186) |
|
purple |
|
|
| modrá navy |
rgb(26,24,105) |
|
navy |
|
|
| frozen green |
rgb(180,211,178) |
|
sage |
|
|
| stříbrná |
rgb(223,231,221) |
rgb(244,245,237) |
grey |
|
|
| zlata |
rgb(208,203,138) |
rgb(237,231,180) |
gold yellow |
|
| rope |
rgb(195,191,163) |
|
cream |
|
|
| dark beige |
rgb(184,155,114) |
|
cream |
|
|
| světle zelená |
rgb(147,227,98) |
|
lime |
|
|
| zelená mint |
rgb(112,207,182) |
|
sage |
|
|
| zelená |
rgb(0,153,51) |
|
green |
|
|
| bordó |
rgb(100,3,23) |
|
burgundy |
|
|
| white |
rgb(255,255,255) |
|
white |
|
|
| black/grey |
rgb(0,0,0) |
rgb(0,0,80) |
black |
grey |
multicolor |
| black/orange |
rgb(0,0,0) |
rgb(237,110,0) |
black |
orange |
multicolor |
| láhvově zelené |
rgb(72,98,79) |
|
bottle |
|
|
| tmavě šedá |
rgb(64,67,79) |
|
dark |
|
|
| šedý melír |
rgb(131,139,156) |
|
dark |
|
|
| limetková |
rgb(207,228,98) |
|
lime |
|
|
| mint green |
rgb(168,224,207) |
|
sage |
|
|
| warm red |
rgb(255,19,61) |
|
red |
|
|
| walnut |
rgb(192,154,118) |
|
brown |
|
|
| peach |
rgb(254,201,1) |
|
orange |
|
|
| cardinal |
rgb(107,30,47) |
|
burgundy |
|
|
| canary red |
rgb(219,2,55) |
|
red |
|
|
| azalea |
rgb(255,134,171) |
|
|
|
|
| ash melange |
rgb(226,224,229) |
|
grey |
|
|
| neon coral |
rgb(231,56,95) |
|
orange |
|
|
| flash pink |
rgb(220,87,150) |
|
pink |
|
|
| camuflage |
rgb(168,165,126) |
rgb(56,77,39) |
army |
|
|
| natural/lime green |
rgb(255,239,195) |
rgb(169,203,94) |
cream |
lime |
multicolor |
| natural/fuchsia |
rgb(255,239,195) |
rgb(223,29,132) |
cream |
pink |
multicolor |
| natural/french navy |
rgb(255,239,195) |
rgb(25,33,112) |
cream |
navy |
multicolor |
| natural/classic red |
rgb(255,239,195) |
rgb(208,3,63) |
cream |
red |
multicolor |
| natural/black |
rgb(255,239,195) |
rgb(0,1,0) |
cream |
black |
multicolor |
| pastel mint |
rgb(220,231,223) |
|
sage |
|
|
| mid grey |
rgb(127,124,119) |
|
grey |
|
|
| acid yellow |
rgb(207,224,92) |
|
lime |
|
|
| tomato |
rgb(227,30,40) |
|
red |
|
|
| soft pink |
rgb(223,182,190) |
|
pink |
|
|
| pacific |
rgb(91,197,213) |
|
blue |
|
|
| light denim melange |
rgb(74,102,149) |
|
denim |
|
|
| irish green |
rgb(1,145,78) |
|
bottle |
|
|
| grenadine |
rgb(241,50,39) |
|
burgundy |
|
|
| gold yellow |
rgb(255,171,47) |
|
gold yellow |
|
| fern green |
rgb(1,146,79) |
|
green |
|
|
| dark royal |
rgb(22,77,145) |
|
blue |
|
|
| dark orange |
rgb(234,88,28) |
|
orange |
|
|
| carmine red melange |
rgb(199,57,69) |
|
red |
|
|
| brown |
rgb(82,67,60) |
|
brown |
|
|
| black heather |
rgb(10,10,10) |
|
black |
|
|
| lilac |
rgb(209,179,214) |
|
purple |
|
|
| light yellow |
rgb(250,232,148) |
|
yellow |
|
|
| charcoal melange |
rgb(8,14,16) |
|
dark |
|
|
| creamy pink |
rgb(254,233,217) |
|
pink |
|
|
| creamy green |
rgb(224,237,215) |
|
sage |
|
|
| creamy blue |
rgb(212,215,226) |
|
sky |
|
|
| light turquoise |
rgb(0,181,216) |
|
turquise |
|
|
| ice mint |
rgb(196,218,231) |
|
sage |
|
|
| green olive |
rgb(68,64,35) |
|
army |
|
|
| fine grey |
rgb(185,185,185) |
|
grey |
|
|
| sport navy |
rgb(38,54,88) |
|
navy |
|
|
| yellow/black |
rgb(245,167,57) |
rgb(0,1,0) |
yellow |
black |
multicolor |
| white/red/royal |
rgb(39,55,114) |
rgb(202,37,41) |
white |
red |
multicolor |
| white/red/black |
rgb(202,37,41) |
rgb(0,0,0) |
white |
red |
multicolor |
| white/olive/orange |
rgb(227,70,20) |
rgb(94,101,54) |
white |
orange |
multicolor |
| white/green |
rgb(71,101,54) |
rgb(250,250,250) |
white |
green |
multicolor |
| white/black/burgundy |
rgb(123,39,50) |
rgb(0,1,0) |
white |
black |
multicolor |
| orange/black |
rgb(232,105,26) |
rgb(107,112,105) |
orange |
black |
multicolor |
| orange fluo |
rgb(250,121,23) |
|
orange |
|
|
| grey/red |
rgb(107,112,105) |
rgb(202,37,41) |
grey |
red |
multicolor |
| green |
rgb(97,171,113) |
|
green |
|
|
| white/white |
rgb(255,255,255) |
rgb(255,255,255) |
white |
|
|
| violet/white |
rgb(71,54,109) |
rgb(255,255,255) |
purple |
white |
multicolor |
| royal/royal |
rgb(39,55,114) |
rgb(39,55,114) |
blue |
|
|
| red/red |
rgb(202,37,41) |
rgb(202,37,41) |
red |
|
|
| olive/black |
rgb(129,120,103) |
rgb(0,1,0) |
army |
black |
multicolor |
| navy/navy |
rgb(35,43,75) |
rgb(35,43,75) |
navy |
|
|
| navy/grey |
rgb(35,43,75) |
rgb(198,197,199) |
navy |
grey |
multicolor |
| mustard/black |
rgb(226,163,0) |
rgb(0,1,0) |
gold yellow |
black |
multicolor |
| khaki/stone |
rgb(214,195,151) |
rgb(219,216,206) |
brown |
cream |
multicolor |
| dark grey/black |
rgb(0,1,2) |
rgb(67,72,74) |
dark |
black |
multicolor |
| burgundy/stone |
rgb(123,39,50) |
rgb(219,216,206) |
burgundy |
cream |
multicolor |
| burgundy/burgundy |
rgb(123,39,50) |
rgb(123,39,50) |
burgundy |
|
|
| black/grey |
rgb(1,0,0) |
rgb(75,75,75) |
black |
grey |
multicolor |
| tyrkysová |
rgb(2,161,199) |
|
turquise |
|
|
| středně zelená |
rgb(2,140,83) |
|
green |
|
|
| neon mandarine |
rgb(228,69,39) |
|
orange |
|
|
| námořní modrá |
rgb(30,47,63) |
|
navy |
|
|
| mátová |
rgb(109,168,150) |
|
sage |
|
|
| královská modrá |
rgb(27,74,146) |
|
blue |
|
|
| yellow fizz |
rgb(255,223,81) |
|
yellow |
|
|
| soft rose |
rgb(240,209,196) |
|
pink |
|
|
| nordic blue |
rgb(95,119,136) |
|
turquise |
|
|
| magenta pink |
rgb(220,26,98) |
|
pink |
|
|
| dark cherry |
rgb(92,35,51) |
|
burgundy |
|
|
| aqua green |
rgb(193,201,199) |
|
sage |
|
|
| crimson red |
rgb(196,29,43) |
|
red |
|
|
| blue midnight |
rgb(14,35,60) |
|
blue |
|
|
| black opal |
rgb(0,0,0) |
|
black |
|
|
| pure sky |
rgb(221,231,233) |
|
sky |
|
|
| pure orange |
rgb(235,93,15) |
|
orange |
|
|
| pink fizz |
rgb(237,104,144) |
|
pink |
|
|
| pale yellow |
rgb(250,241,215) |
|
yellow |
|
|
| melon orange |
rgb(246,170,112) |
|
orange |
|
|
| light jade |
rgb(201,219,174) |
|
sage |
|
|
| heather royal blue |
rgb(66,90,151) |
|
blue |
|
|
| heather red |
rgb(225,26,59) |
|
red |
|
|
| heather purple |
rgb(113,77,105) |
|
purple |
|
|
| heather navy |
rgb(73,79,101) |
|
navy |
|
|
| heather mid grey |
rgb(114,119,122) |
|
grey |
|
|
| heather dark green |
rgb(69,94,88) |
|
bottle |
|
|
| heather asphalt |
rgb(64,69,73) |
|
dark |
|
|
| grey fog |
rgb(216,210,192) |
|
cream |
|
|
| elephant grey |
rgb(130,118,121) |
|
grey |
|
|
| desert |
rgb(206,181,150) |
|
cream |
|
|
| asphalt |
rgb(67,63,66) |
|
dark |
|
|
| black/black |
rgb(0,0,0) |
rgb(0,0,0) |
black |
|
|
| amber |
rgb(218,147,45) |
|
gold yellow |
|
| pastel pink |
rgb(236,220,218) |
|
pink |
|
|
| true pink |
rgb(236,127,168) |
|
pink |
|
|
| surf blue |
rgb(0,179,225) |
|
blue |
|
|
| sunflower |
rgb(255,215,118) |
|
yellow |
|
|
| raspberry pink |
rgb(235,87,119) |
|
pink |
|
|
| pastel blue |
rgb(223,228,237) |
|
sky |
|
|
| orange rust |
rgb(186,76,40) |
|
orange |
|
|
| mint |
rgb(158,211,199) |
|
sage |
|
|
| magenta |
rgb(168,34,84) |
|
pink |
|
|
| kiwi |
rgb(149,17,13) |
|
lime |
|
|
| classic red |
rgb(208,3,63) |
|
red |
|
|
| classic pink |
rgb(233,160,199) |
|
pink |
|
|
| caramel |
rgb(169,106,46) |
|
brown |
|
|
| steel blue |
rgb(51,65,94) |
|
blue |
|
|
| graphite grey |
rgb(80,82,80) |
|
grey |
|
|
| bright royal |
rgb(25,51,122) |
|
blue |
|
|
| blush |
rgb(243,157,147) |
|
cream |
|
|
| black |
rgb(20,20,2) |
|
black |
|
|
| yellow fluo |
rgb(229,225,54) |
|
yellow |
|
|
| violet |
rgb(88,84,143) |
|
purple |
|
|
| pink |
rgb(243,162,189) |
|
pink |
|
|
| off red |
rgb(162,15,59) |
|
red |
|
|
| navy melange |
rgb(23,43,76) |
|
navy |
|
|
| light blue |
rgb(108,181,210) |
|
sky |
|
|
| grey |
rgb(67,72,74) |
|
grey |
|
|
| green fluo |
rgb(90,221,69) |
|
lime |
|
|
| fuchsia fluo |
rgb(218,24,132) |
|
pink |
|
|
| coral |
rgb(214,105,101) |
|
orange |
|
|
| burgundy melange |
rgb(101,29,50) |
|
burgundy |
|
|
| beige |
rgb(190,172,150) |
|
cream |
|
|
| avio |
rgb(44,85,116) |
|
blue |
|
|
| mustard |
rgb(198,146,20) |
|
gold yellow |
|
| hot chocolate |
rgb(56,46,44) |
|
brown |
|
|
| silver |
rgb(156,155,167) |
|
grey |
|
|
| light charcoal |
rgb(83,82,87) |
|
dark |
|
|
| loden |
rgb(137,125,103) |
|
army |
|
|
| wild mulberry |
rgb(92,78,99) |
|
burgundy |
|
|
| ultra violet |
rgb(51,0,114) |
|
purple |
|
|
| turquoise surf |
rgb(5,195,221) |
|
turquise |
|
|
| true violet |
rgb(149,149,210) |
|
purple |
|
|
| steel grey |
rgb(84,88,89) |
|
dark |
|
|
| sherbet lemon |
rgb(239,225,162) |
|
yellow |
|
|
| shark grey |
rgb(81,80,88) |
|
dark |
|
|
| red rust |
rgb(124,66,60) |
|
brown |
|
|
| pumpkin pie |
rgb(200,118,41) |
|
orange |
|
|
| pinky purple |
rgb(198,87,154) |
|
purple |
|
|
| peach perfect |
rgb(277,189,168) |
|
cream |
|
|
| orange crush |
rgb(255,105,0) |
|
orange |
|
|
| navy smoke |
rgb(31,42,68) |
|
navy |
|
|
| natural stone |
rgb(219,215,204) |
|
cream |
|
|
| moss green |
rgb(42,120,108) |
|
army |
|
|
| moondust grey |
rgb(213,213,213) |
|
grey |
|
|
| mocha brown |
rgb(131,124,117) |
|
brown |
|
|
| magenta magic |
rgb(140,71,153) |
|
purple |
|
|
| lipstick pink |
rgb(239,66,111) |
|
pink |
|
|
| lime green |
rgb(121,199,83) |
|
lime |
|
|
| lagoon blue |
rgb(0,132,145) |
|
turquise |
|
|
| chocolate fudge brownie |
rgb( 102,70,68) |
|
brown |
|
|
| graphite heather |
rgb(132,131,136) |
|
grey |
|
|
| festival fuchsia |
rgb(163,33,105) |
|
pink |
|
|
| dusty lilac |
rgb(153,145,158) |
|
purple |
|
|
| vanilla milkshake |
rgb(241,230,178) |
|
cream |
|
|
| sun yellow |
rgb(249,218,0) |
|
yellow |
|
|
| storm grey |
rgb(61,61,61) |
|
dark |
|
|
| sapphire blue |
rgb(0,94,184) |
|
blue |
|
|
| red hot chili |
rgb(124,37,44) |
|
burgundy |
|
|
| plum |
rgb(105,61,97) |
|
purple |
|
|
| peppermint |
rgb(137,228,219) |
|
sage |
|
|
| oxford navy |
rgb(38,36,57) |
|
navy |
|
|
| nude |
rgb(220,203,184) |
|
pink |
|
|
| new french navy |
rgb(38,37,55) |
|
navy |
|
|
| digital lavender |
rgb(137,120,174) |
|
purple |
|
|
| tropical blue |
rgb(0,125,166) |
|
purple |
|
|
| purple |
rgb(128,87,130) |
|
purple |
|
|
| oxford grey |
rgb(177,177,181) |
|
grey |
|
|
| ash heather |
rgb(201,201,201) |
|
grey |
|
|
| neon yellow |
rgb(241,228,3) |
|
yellow |
|
|
| neon pink |
rgb(233,67,133) |
|
pink |
|
|
| neon orange |
rgb(255,153,51) |
|
orange |
|
|
| neon green |
rgb(183,205,1) |
|
lime |
|
|
| light sand |
rgb(221,194,165) |
|
cream |
|
|
| light royal blue |
rgb(28,108,173) |
|
blue |
|
|
| alien green |
rgb(143,169,70) |
|
green |
|
|
| airforce blue |
rgb(79,117,139) |
|
blue |
|
|
| ancient pink |
rgb(232,147,179) |
|
burgundy |
|
|
| apple green |
rgb(108,194,74) |
|
green |
|
|
| apricot |
rgb(253,133,76) |
|
yellow |
|
|
| aqua |
rgb(1,161,241) |
|
blue |
|
|
| arctic white |
rgb(255,255,255) |
|
white |
|
|
| army |
rgb(66,58,51) |
|
army |
|
|
| ash |
rgb(222,222,222) |
|
grey |
|
|
| atoll blue |
rgb(34,140,204) |
|
turquise |
|
|
| azure |
rgb(61,115,176) |
|
blue |
|
|
| baby pink |
rgb(245,182,205) |
|
pink |
|
|
| bear brown |
rgb(124,88,59) |
|
brown |
|
|
| bílá |
rgb(255,255,255) |
|
white |
|
|
| black pure |
rgb(0,0,0) |
|
black |
|
|
| black smoke |
rgb(67,76,85) |
|
black |
|
|
| blue |
rgb(31,93,217) |
|
blue |
|
|
| blue fog |
rgb(162,202,227) |
|
sky |
|
|
| bottle green |
rgb(25,88,61) |
|
bottle |
|
|
| brick red |
rgb(152,44,42) |
|
burgundy |
|
|
| bright red |
rgb(203,65,84) |
|
red |
|
|
| burgundy |
rgb(121,33,64) |
|
burgundy |
|
|
| burgundy smoke |
rgb(155,54,68) |
|
burgundy |
|
|
| burnt orange |
rgb(218,132,61) |
|
orange |
|
|
| camel |
rgb(189,162,128) |
|
brown |
|
|
| candy pink |
rgb(231,130,169) |
|
pink |
|
|
| candyfloss pink |
rgb(207,75,117) |
|
pink |
|
|
| caramel latte |
rgb(193,142,99) |
|
brown |
|
|
| caramel toffee |
rgb(127,87,53) |
|
brown |
|
|
| caribbean blue |
rgb(44,146,135) |
|
turquise |
|
|
| cobalt blue |
rgb(22,70,145) |
|
blue |
|
|
| combat green |
rgb(89,89,64) |
|
army |
|
|
| cornflower blue |
rgb(37,77,136) |
|
sky |
|
|
| cranberry |
rgb(126,11,28) |
|
burgundy |
|
|
| cream |
rgb(222,210,192) |
|
cream |
|
|
| černá |
rgb(0,0,0) |
|
black |
|
|
| červená |
rgb(222,16,16) |
|
red |
|
|
| dark green |
rgb(26,39,14) |
|
bottle |
|
|
| dark grey |
rgb(81,84,94) |
|
dark |
|
|
| dark khaki |
rgb(110,114,99) |
|
brown |
|
|
| dark olive |
rgb(40,54,28) |
|
army |
|
|
| dark purple |
rgb(66,35,105) |
|
purple |
|
|
| deep black |
rgb(0,0,0) |
|
black |
|
|
| deep green |
rgb(88,96,83) |
|
army |
|
|
| deep red |
rgb(153,32,30) |
|
red |
|
|
| deep sea blue |
rgb(42,65,79) |
|
blue |
|
|
| denim |
rgb(65,87,125) |
|
denim |
|
|
| desert sand |
rgb(227,210,128) |
|
cream |
|
|
| diva blue |
rgb(50,75,105) |
|
turquise |
|
|
| duck blue |
rgb(44,154,144) |
|
turquise |
|
|
| dusty blue |
rgb(148,186,227) |
|
sky |
|
|
| dusty green |
rgb(135,137,115) |
|
sage |
|
|
| dusty pink |
rgb(236,160,186) |
|
pink |
|
|
| dusty purple |
rgb(198,107,136) |
|
purple |
|
|
| dusty rose |
rgb(209,152,158) |
|
pink |
|
|
| eart |
rgb(124,88,59) |
|
brown |
|
|
| earth |
rgb(124,88,59) |
|
brown |
|
|
| earthy green |
rgb(74,111,87) |
|
bottle |
|
|
| electric blue |
rgb(37,77,136) |
|
blue |
|
|
| emerald |
rgb(44,154,144) |
|
bottle |
|
|
| fire red |
rgb(200,10,27) |
|
red |
|
|
| flint stone |
rgb(87,94,113) |
|
grey |
|
|
| forest green |
rgb(1,73,49) |
|
bottle |
|
|
| french navy |
rgb(50,75,105) |
|
navy |
|
|
| fuchsia |
rgb(159,44,119) |
|
pink |
|
|
| ginger biscuit |
rgb(230,186,97) |
|
orange |
|
|
| gold |
rgb(243,198,42) |
|
gold yellow |
|
| grafitová |
rgb(64,64,64) |
|
dark |
|
|
| grape |
rgb(105,70,102) |
|
burgundy |
|
|
| grey heather |
rgb(183,183,183) |
|
grey |
|
|
| grey melange |
rgb(183,183,183) |
|
dark |
|
|
| hawaiian blue |
rgb(44,154,144) |
|
turquise |
|
|
| hibiscus |
rgb(198,107,136) |
|
red |
|
|
| hnědá |
rgb(117,81,57) |
|
brown |
|
|
| hot pink |
rgb(198,107,136) |
|
pink |
|
|
| charcoal |
rgb(102,105,113) |
|
dark |
|
|
| chili red |
rgb(153,32,30) |
|
red |
|
|
| chocolate |
rgb(89,63,51) |
|
brown |
|
|
| ice blue |
rgb(98,134,166) |
|
sky |
|
|
| indigo |
rgb(17,40,71) |
|
navy |
|
|
| ink blue |
rgb(65,87,125) |
|
blue |
|
|
| jade |
rgb(44,146,135) |
|
sage |
|
|
| jet black |
rgb(20,20,20) |
|
black |
|
|
| kelly green |
rgb(118,186,85) |
|
green |
|
|
| khaki |
rgb(152,150,122) |
|
brown |
|
|
| kit |
rgb(205,180,149) |
|
brown |
|
|
| korálová |
rgb(246,92,85) |
|
orange |
|
|
| lavender |
rgb(179,169,193) |
|
purple |
|
|
| leaf green |
rgb(135,137,115) |
|
army |
|
|
| lemon |
rgb(255,188,74) |
|
yellow |
|
|
| light grey |
rgb(199,199,201) |
|
grey |
|
|
| light navy |
rgb(16,46,83) |
|
navy |
|
|
| light purple |
rgb(205,162,204) |
|
purple |
|
|
| lime |
rgb(118,186,85) |
|
lime |
|
|
| medium pink |
rgb(249,182,199) |
|
pink |
|
|
| millennial khaki |
rgb(196,188,169) |
|
army |
|
|
| millennial lilac |
rgb(179,169,193) |
|
purple |
|
|
| millennial mint |
rgb(145,192,186) |
|
sage |
|
|
| millennial pink |
rgb(244,202,214) |
|
pink |
|
|
| millennial purple |
rgb(140,83,157) |
|
purple |
|
|
| modrá |
rgb(0,0,255) |
|
blue |
|
|
| modrá aqua |
rgb(131,199,230) |
|
blue |
|
|
| modrošedá |
rgb(121,159,184) |
|
blue |
|
|
| mouse grey |
rgb(87,94,113) |
|
dark |
|
|
| natural |
rgb(220,210,163) |
|
cream |
|
|
| navy |
rgb(12,46,83) |
|
navy |
|
|
| navy blue |
rgb(16,46,83) |
|
navy |
|
|
| off white |
rgb(255,255,255) |
|
white |
|
|
| olive |
rgb(40,54,28) |
|
army |
|
|
| Olivová |
rgb(53,66,42) |
|
army |
|
|
| oranžová |
rgb(232,88,25) |
|
orange |
|
|
| orchid green |
rgb(118,186,85) |
|
lime |
|
|
| orchid pink |
rgb(236,160,186) |
|
pink |
|
|
| pacific grey |
rgb(195,194,194) |
|
grey |
|
|
| pale pink |
rgb(244,202,214) |
|
pink |
|
|
| petrolejová |
rgb(42,65,79) |
|
turquise |
|
|
| pink sixties |
rgb(236,82,134) |
|
pink |
|
|
| pistachio |
rgb(211,220,53) |
|
green |
|
|
| pixel lime |
rgb(178,220,53) |
|
lime |
|
|
| pouštní |
rgb(227,223,174) |
|
cream |
|
|
| powder grey |
rgb(102,105,113) |
|
dark |
|
|
| pure grey |
rgb(195,194,194) |
|
grey |
|
|
| radiant purple |
rgb(66,35,105) |
|
purple |
|
|
| real turrquoise |
rgb(7,159,193) |
|
turquise |
|
|
| rose |
rgb(208,140,161) |
|
pink |
|
|
| royal blue |
rgb(20,53,130) |
|
blue |
|
|
| růžová |
rgb(242,158,184) |
|
pink |
|
|
| sage green |
rgb(190,212,144) |
|
sage |
|
|
| sand |
rgb(180,142,120) |
|
cream |
|
|
| sky blue |
rgb(162,202,227) |
|
sky |
|
|
| soft grey |
rgb(217,219,218) |
|
grey |
|
|
| solar yellow |
rgb(255,193,70) |
|
yellow |
|
|
| sorbet |
rgb(236,160,186) |
|
pink |
|
|
| sport grey |
rgb(199,199,201) |
|
grey |
|
|
| spring green |
rgb(136,143,112) |
|
green |
|
|
| stone |
rgb(209,199,189) |
|
cream |
|
|
| stone blue |
rgb(98,134,166) |
|
blue |
|
|
| sunset orange |
rgb(232,88,25) |
|
orange |
|
|
| světle modrá |
rgb(101,182,226) |
|
sky |
|
|
| světle růžová |
rgb(255,204,204) |
|
pink |
|
|
| světle šedá |
rgb(204,204,204) |
|
grey |
|
|
| swimming pool |
rgb(114,135,182) |
|
blue |
|
|
| šedá |
rgb(153,153,153) |
|
grey |
|
|
| tango red |
rgb(126,11,28) |
|
burgundy |
|
|
| terracotta |
rgb(212,100,25) |
|
burgundy |
|
|
| tmavě modrá |
rgb(0,51,153) |
|
blue |
|
|
| turquoise |
rgb(33,213,222) |
|
turquise |
|
|
| ultramarine |
rgb(37,77,136) |
|
blue |
|
|
| urban khaki |
rgb(110,114,99) |
|
army |
|
|
| urban orange |
rgb(232,88,25) |
|
orange |
|
|
| urban purple |
rgb(66,35,105) |
|
purple |
|
|
| used black |
rgb(36,35,33) |
|
black |
|
|
| vínová |
rgb(120,26,75) |
|
burgundy |
|
|
| woodland |
rgb(111,104,65) |
|
army |
|
|
| yellow |
rgb(255,255,0) |
|
yellow |
|
|
| zelená |
rgb(51,204,51) |
|
green |
|
|
| zinc |
rgb(135,137,115) |
|
grey |
|
|
| žlutá |
rgb(255,255,0) |
|
blue |
|
|
| black/red |
rgb(0,0,0) |
rgb(255,0,0) |
black |
red |
multicolor |
| azure/navy |
rgb(61,115,176) |
rgb(12,46,83) |
blue |
navy |
multicolor |
| carbon/orange |
rgb(50,50,50) |
rgb(255,165,0) |
dark |
orange |
multicolor |
| grey heather/purple |
rgb(183,183,183) |
rgb(128,87,130) |
grey |
purple |
multicolor |
| navy/red |
rgb(12,46,83) |
rgb(255,0,0) |
navy |
red |
multicolor |
| navy/aqua |
rgb(12,46,83) |
rgb(1,161,241) |
navy |
blue |
multicolor |
| olive/lime green |
rgb(40,54,28) |
rgb(121,199,83) |
army |
lime |
multicolor |
| red/carbon |
rgb(255,0,0) |
rgb(50,50,50) |
red |
dark |
multicolor |
| sport grey/navy |
rgb(199,199,201) |
rgb(12,46,83) |
grey |
navy |
multicolor |
| black/carbon |
rgb(0,0,0) |
rgb(50,50,50) |
black |
dark |
multicolor |
| fern green/graphite |
rgb(33,169,58) |
rgb(80,82,80) |
green |
dark |
multicolor
|
| test |
rgb(0,0,0) |
|
|
|
|
Barevné varianty
|